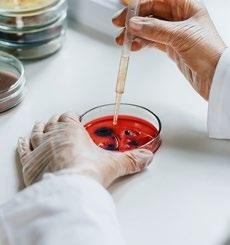

die lobby
DAS MAGAZIN DER ÖSTERREICHISCHEN HOTELIERVEREINIGUNG
instagram.com/ oehv.hoteliervereinigung
linkedin.com/company/ österreichische-hoteliervereinigung facebook.com/ hoteliervereinigung




instagram.com/ oehv.hoteliervereinigung
linkedin.com/company/ österreichische-hoteliervereinigung facebook.com/ hoteliervereinigung



Wir haben schon vieles gemeistert. Ob Wirtschaftskrise, Pandemie oder Energiepreisschock – die österreichische Hotellerie hat immer gezeigt, dass sie mehr ist als nur ein Dienstleistungssektor. Sie ist ein Rückgrat der heimischen Wirtschaft, ein Arbeitsplatzmotor und international gefeierter Botschafter unseres Landes.
Die Betriebe bringen weiterhin ihre Leistung, stehen aber zusehends unter Druck. Das zeigen auch die Ergebnisse unserer aktuellen ÖHV-Inside Umfrage: Zwar steigen die Umsätze, doch am Ende des Tages bleibt immer weniger über. Betriebs- und Energiekosten werden zur Dauerbelastung, der immer preissensitivere Gäste gegenüberstehen. Die Kosten zur Gänze weitergeben ist unmöglich.
Es braucht einen Wandel. Die neue Bundesregierung hat die historische Chance, diesen auch endlich zu vollziehen und Worten auch Taten folgen zu lassen. Wir, als Hotellerie und ÖHV, sind bereit diesen Tournaround mitzugehen, aktiv mitzugestalten und gemeinsam für ein besseres Österreich jetzt und in Zukunft zu arbeiten.
Ich wünsche Ihnen eine gute Wintersaison, ein paar ruhige Stunden mit Ihren Liebsten während der Festtage und freu mich, Sie dann von 22. bis 24. Jänner am ÖHV-Kongress in Innsbruck willkommen zu heißen.
Euer
Walter Veit
Präsident der Österreichischen Hoteliervereinigung

IMPRESSUM
Medieninhaber, Herausgeber und Hersteller: Österreichische Hoteliervereinigung, Hofburg, 1010 Wien Für den Inhalt verantwortlich: Dr. Markus Gratzer, Redaktions- und Projektleitung: Mag. Claudia Bär 1010 Wien, T: +43 1 5330952-0, office@oehv.at, www.oehv.at, "die lobby" erscheint 4x jährlich, Jahresabo 61,00 Euro (inkl. 10 % MwSt., exkl. Versandspesen), Angaben zur Offenlegung: oehv.at/lobby-offenlegung
Druck: Gutenberg Druck in Kooperation mit Print Alliance HAV Produktions GmbH, 2540 Bad Vöslau. Produziert nach den Richtlinien des Österreichischen Umweltzeichens, UW-Nr. 837. Grafische Gestaltung: www.br-design.at
Für Inhalte dieser Publikation, die von Dritten stammen, übernimmt die ÖHV keine Haftung.




04 KURZ & BÜNDIG
06 TOURISMUSPOLITIK
Wie Österreich zum Gewinner wird
08 ÖHV-INSIDE
So wird der Winter
10 ALLES WAS RECHT IST
12
HOTELMARKT
Spannende Neu- und Wiedereröffnungen
20 TRANSFORMATION
Das Mindset für eine erfolgreiche Zukunft
22 KÜNSTLICHE INTELLIGENZ
Wie KI den Tourismus verändert
24 TOURISMUSMARKETING
Wo kommen in Zukunft die Gäste her?
26 SEGMENTIERUNG
Von Zielgruppen zu Stilgruppen
28 STUDIE
5 Fakten zur Gen Z
30 GÄSTE
Generation Z als Wirtschaftsfaktor
32 DIGITALISIERUNG
Fluch oder Segen?
34 SOCIAL MEDIA
Von Google zu Tiktok
36 WANDEL
Wintersport, quo vadis?
38 CYBERCRIME
Gefahren der KI
40 ÖHV-KONGRESS
42 ÖHV-CAMPUS
Neue Webinar-Reihen 2025
46 WIR SIND ÖHV
Neue Mitglieder im 4. Quartal
Unser Impressum finden Sie auf Seite 2
Ab 01.01.2025 wird für Einweggetränkeverpackungen aus Kunststoff und Metall mit einem Volumen von 0,1 bis max. 3 Liter ein Pfand in Höhe von 25 Cent eingeführt. Wir haben zusammengefasst, was das für die Hotellerie bedeutet.
oehv.at/einwegpfand
Michael Jayasekara und Sarah Danne von vionmo haben für die ÖHV einen Online-Leitfaden erstellt, der noch nicht berichtspflichtigen Hotels bei der Erstellung eines ESG-Nachhaltigkeitsberichtes hilft. Wie´s geht, erklären sie Schritt für Schritt auch beim Online-Talk – kostenlos zum Nachschauen auf oehv.at.
oehv.at/esg-leitfaden
Unterwegs in den Bundesländern
Um den Tourismus als starken Wirtschaftsfaktor im Burgenland ging es bei einer Podiumsdiskussion auf Einladung der „Initiative für Demokratie“. Mit am Podium: ÖHV-Vizepräsident Klaus Hofmann
Mit LAbg. Michael Nell, FGO Hotellerie, trafen sich Sophie Schick und Monika Tonner-Fiechtl zum Austausch über oö. Branchenthemen.
Über Bettenkapazitäten, Busgäste und AirBnB sprach Präsident Walter Veit u.a. mit dem Salzburger Bürgermeister Bernhard Auinger

BUCH-TIPP:

Mensch und Maschine: Wie Künstliche Intelligenz und Roboter unser Leben verändern von Thomas Ramge Erschienen im Reclam Verlag Auf weniger als 100 Seiten beleuchtet dieses Taschenbuch, wie KI und Automatisierung das Leben und Arbeiten verändern und hinterfragt, welche Rolle menschliche Fähigkeiten und Werte dabei spielen. Ramge plädiert für einen bewussten Umgang mit Technologien und zeigt auf, warum menschliche Qualitäten wie Empathie in einer zunehmend digitalen Welt essenziell bleiben.

Der Buch-Tipp wurde ausgewählt von unserer Campus-Leiterin Brigitta Brunner, BA
Tourismusstruktur und -finanzierung, Erlebnisregionen und öffentliche Mobilität standen im Mittelpunkt des Landtagswahlchecks der ÖHV-Steiermark.
Zum jährlichen Jourfixe traf man sich mit Vertreter:innen der steirischen Tourismusgesellschaft (STG).
Mit Fragen zu Arbeitsmarkt, Entwicklung des Tourismusstandorts und Organisation des Vorarlberger Tourismus befasste das Ländle-Team die wahlwerbenden Parteien zur Landtagswahl

Kryotherapie für ganzheitliches Wohlbefinden liegt absolut im Trend. Die österreichische Marke ArctiSync bietet hier ein einzigartiges Wellness-Erlebnis bei garantierten -110°C und konkurrenzloser Energie-Effizienz.
In den letzten Jahren ist mit der Kältetherapie („Kryotherapie“) ein ausgeprägter Wellness-Boom entstanden, dem sich auch immer mehr Hotels anschließen. Schon nach einem kurzen Aufenthalt von nur drei Minuten fühlen sich Nutzer:innen von Kältekammern wie neu geboren. Schmerzlinderung, Stärkung des Immunsystems, Ankurbelung des Stoffwechsels sowie bessere Durchblutung sind nur einige der vielen positiven Effekte. Zudem werden Endorphine freigesetzt und Wohlbefinden sowie Regeneration sind lang anhaltend.
Die Kältetherapie stellt für mich als Orthopäde und Sportarzt eine effektive Methode dar, um Verletzungen und Beschwerden am Stütz-Bewegungsapparat präventiv vorzubeugen. Weiters sehe ich durch die entzündungshemmende Wirkung einen großen Benefit im Umgang mit chronischen Erkrankungen.

DR. MARTIN RESCHL Orthopäde und Sportarzt www.healthdoctors.at
Mit mehr als 20 Jahren Erfahrung setzen die KryoExpertinnen und -Experten der österreichischen Marke ArctiSync bei Kältekammern auf einzigartige Spitzentechnologie. Der Fokus liegt auf Leistung, Technik und Nachhaltigkeit. Die konkurrenzlos hohe Energieeffizienz ergibt sich dabei durch die weltweit patentierte neue ArctiSync-Kühltechnologie. Die Kammern aus Österreich bieten erstklassige Wellness- und Gesundheitserfahrungen für Gäste und bieten ein attraktive neue Umsatzquelle, die das Image des Wellnessangebots deutlich anhebt.


Cooles Wellness-Erlebnis
ArctiSync Kältekammern kommen dabei ohne umweltschädliche Kühlmittel aus und kühlen schneller, effizienter und kostensparender. Die Marke folgt den ESG-Prinzipen und ist somit eine ideale Wahl sowohl für Kryotherapie-Anwendungen in Resorts und Hotels als auch für physikalische Therapien bzw. für die Sportmedizin.
Die Kryotherapie eröffnet unseren Gästen neue Behandlungsmöglichkeiten auf ganzheitlicher Ebene. Die innovative Technologie von ArctiSync sehen wir als optimale Ergänzung unseres bereits breit aufgestellten Therapiespektrums.
ArctiSync GmbH, Große Schiffgasse 2/23, 1020 Wien © healthdoctors.at

MAG. ANDREAS LEITNER
Geschäftsführer REDUCE Gesundheitsresort Bad Tatzmannsdorf www.reduce.at
Alle Informationen: arctisync.com
KONTAKT
Österreich steht vor einer wirtschaftlichen Neuorientierung, geprägt von globalen Unsicher heiten, strukturellen Herausforderungen und politischen Weichenstellungen. Die Tourismusbranche, einer der zentralen Wirtschaftsmotoren, sieht sich dabei wachsenden Herausforderungen gegenüber.
Wirtschaft: Ein zaghafter Hoffnungsschimmer
Die mittelfristige Prognose des WIFO zeichnet ein Bild verhaltener Erholung für die österreichische Wirtschaft. Nach einem BIP-Wachstum von lediglich 1 % im Jahr 2024 wird für 2025 ein Anstieg auf 1,5 % erwartet. Dennoch bleibt Österreich hinter dem EU-Durchschnitt zurück. Gründe dafür sind die weiterhin hohe Inflation, sowie die hohen Zinsen, die Investitionen hemmen. Besonders KMU – das oft beschworene Rückgrat der Wirtschaft – leiden unter den gestiegenen Finanzierungskosten.
Ab 2026 stehen die Zeichen auf Stabilisierung, wobei das Wachstum auf etwa 2 % ansteigen könnte. Wesentliche Treiber sind der Nachholbedarf bei Investitionen, Fördermaßnahmen für nachhaltige Technologien und Digitalisierung sowie Exportchancen durch eine verbesserte globale Konjunktur. Dennoch bleiben strukturelle Probleme bestehen. Der Arbeitskräftemangel bleibt aufgrund niedriger Geburtenraten und hoher Teilzeitquoten eine Herausforderung.
Die hohe Steuer- und Abgabenlast dämpft die Wettbewerbsfähigkeit, und bürokratische Hürden erschweren Unternehmen die Umsetzung neuer Projekte.
Politische Weichenstellungen:
Alles auf Neustart (und der ist wichtig!)
Die politischen Rahmenbedingungen in Österreich befinden sich im Wandel. Egal wie die zukünftige Regierung auch aussieht, eines ist klar, es braucht einen Neustart. Wirtschaftliche Impulse, eine Steuerentlastung, die endlich einmal auch ihren Namen verdient, ein modernes Arbeitsrecht für einen modernen Arbeitsmarkt und die echte Umsetzung der seit Jahrzehnten als Wahlversprechen mit Augenzwinkern
versprochenen Bürokratiereform. Für den Tourismus dabei zudem essenziell: Eine klare und ambitionierte Strategie, um die Branche nachhaltig zu stärken.
Tourismus: Der Motor stottert, läuft aber
Die Hotellerie zeigt nach der Pandemie Resilienz, bleibt jedoch in einer angespannten Lage. Laut dem aktuellen Deloitte ÖHV-Tourismusbarometer erwarten 60 % der Betriebe steigende Umsätze, jedoch wird die wirtschaftliche Lage der Branche skeptischer bewertet als die der Gesamtwirtschaft. Große Herausforderungen in den großen Zukunftsbereichen stehen an:
• Arbeitskräftemangel: Der demografische Wandel und ein unflexibler Arbeitsmarkt erschweren das Recruiting. Die niedrige Geburtenrate und mangelnde Betreuungsangebote sind strukturelle Schwächen.
• Steuer- und Abgabenlast: Österreich gehört zu den Ländern mit der höchsten Steuerquote in der EU. Dies schmälert die Investitionskraft der Unternehmen und erhöht die Arbeitskosten. Unsere Mitarbeiter:innen kosten zu viel und verdienen zu wenig.
• Digitalisierung und Technologie: Der Wettbewerb wird zunehmend digital. Österreichische Hotels sind europaweit führend bei der Nutzung von KI, jedoch bestehen Lücken bei digitalen Infrastrukturen und Weiterbildungsangeboten.
• Nachhaltigkeit und Klimawandel: Extremwetterereignisse, Wasserknappheit und sich verändernde Gästepräferenzen erfordern nachhaltige Strategien. Eine intakte Natur bleibt ein essenzieller USP.
Anpacken bei der Arbeitsmarktpolitik
• Flexiblere Kinderbetreuung: Einführung von Betreuungsangeboten, die den Arbeitszeiten in der Tourismusbranche gerecht werden, inklusive Abend- und Wochenendbetreuung.
• Attraktivere Arbeitsbedingungen: Einführung steuerfreier Zuschläge für Überstunden und Wochenendarbeit. Zusätzlich sollten Lohnnebenkosten drastisch gesenkt werden.
Bürokratie entschlacken, Unternehmen entlasten
• Einführung eines Bürokratiechecks: Neue Regulierungen sollten vorab auf ihre Umsetzbarkeit geprüft werden.
• Steuerlast senken: Eine Senkung der Lohnnebenkosten, eine Halbierung der Lohnsteuer für junge Beschäftigte und vollständige Steuerbefreiung für Überstunden wären ein starkes Signal an die Arbeitswelt.
Digitalisierung forcieren
• Breitband- und Mobilfunkausbau: Schnelles Internet in allen Regionen, auch in ländlichen Gebieten, ist Voraussetzung für digitale Transformation.
• Weiterbildung: Schulungen und Bildungsoffensiven zu digitalen Tools und KI für Mitarbeiter:innen und Führungskräfte, damit Österreichs Hotellerie führend bei KI & Co. bleibt.
Nachhaltigkeit als Stärke nutzen
• Förderung grüner Technologien: Investitionen in nachhaltige Energiequellen und Maßnahmen zur CO2-Reduktion müssen verstärkt werden. Förderprogramme müssen vor allem auch kleine und mittlere Betriebe adressieren.
• Bewusstseinsbildung bei Gästen und Betrieben: Nachhaltigkeit als Qualitätsmerkmal etablieren, etwa durch klimaneutrale Angebote und regionale Produkte.
Jetzt oder nie
Die Tourismus- und Hotelleriebranche ist bereit, die Herausforderungen anzunehmen. Aber sie braucht Unterstützung. Politik, Wirtschaft und Gesellschaft müssen jetzt an einem Strang ziehen.
Österreich hat alles, was es braucht, um als internationales Vorbild im Qualitätstourismus zu glänzen.
Jetzt gilt es, die Chancen zu nutzen –mit Mut, Weitblick und Entschlossenheit.
Mehr zu den ÖHV-Positionen für eine nachhaltig erfolgreiche Tourismuszukunft finden Sie unter oehv.at/tourismuszukunft
Positive Buchungsentwicklung mit erheblichen Belastungen: Steigende Betriebskosten, schwierige Preisgestaltung und ein anhaltender Fachkräftemangel stellen die Betriebe vor große Belastungen.
Die große ÖHV-Inside-Befragung zur Wintersaison zeigt ein gemischtes Bild: Rund 42 % der befragten Hotels erwarten im Vergleich zum Vorjahr eine Zunahme an Nächtigungen. Ein signifikanter Anteil (39 %) rechnet hingegen mit einem Rückgang, was auf eine teilweise unsichere Buchungslage hindeutet.
Nächtigungsentwicklung ggü. Winter 23/24

Umsätze: Höhere Nachfrage bei fordernden Rahmenbedingungen
In punkto Umsätze ist die Stimmungslage etwas positiver: Mehr als die Hälfte der Befragten (59 %) geht von einer Umsatzsteigerung aus. Dennoch rechnen rund ein Drittel mit sinkenden Einnahmen, was in Kombination mit den steigenden Betriebskosten eine Herausforderung darstellt. Diese Ergebnisse verdeutlichen, dass viele Hotels zwar eine erhöhte Nachfrage erwarten, diese jedoch mit Vorsicht betrachten, da die wirtschaftlichen Rahmenbedingungen schwierig bleiben.
Preis und Kostenweitergabe: es bleibt schwierig
Die Umfrage zeigt eine große Zurückhaltung der Betriebe, die gestiegenen Betriebskosten an die Gäste weiterzugeben. Lediglich 14 % der befragten Hotels geben an, ihre höheren Kosten vollständig weiterzureichen. Die Mehrheit (70 %) legt die Kosten nur teilweise um, während 16 % die Preise stabil halten. Dies verdeutlicht die Spannung, unter der viele Hotels stehen: Einerseits versuchen sie, die Preisattraktivität aufrechtzuerhalten, um Gäste nicht abzuschrecken, andererseits sehen sich viele Betriebe durch die nicht vollständig weitergegebenen Kostensteigerungen gezwungen, ihre Gewinnmargen zu schmälern.
Diese Preisdrucksituation führt dazu, dass nur eine Minderheit von 15 % die Preisdurchsetzung als positiv bewertet, während 32 % eine Verschlechterung in der Preisgestaltung beklagen.
Herausforderung: Das neue Buchungsverhalten der Gäste
Das geänderte Buchungsverhalten der Gäste stellt eine der größten Herausforderungen dar. Zwei Drittel der Gäste buchen kurzfristiger, 6 von 10 reduzieren ihre Nebenausgaben bei Speisen, Getränken oder im Spa. 58 % verkürzen ihren Aufenthalt und ein Drittel der Gäste entscheidet sich für eine niedrigere Zimmerkategorie. Diese Unsicherheiten erschweren die Planbarkeit für die Betriebe und fordern hohe Flexibilität, insbesondere in der Mitarbeiter:innenplanung und Kostenstruktur.
Buchungs- und Urlaubsverhalten
Kurzfristigere Buchungen
Reduktion Nebenausgaben
Kürzerer Aufenthalt
Niedrigere Zimmerkategorie
Unverändert
Weniger Aufenthalte
Höhere Zimmerkategorie
Mehr Nebenausgaben
Die Prognosen zur wirtschaftlichen Entwicklung der Betriebe zeigen ein gemischtes Bild. Während 37 % Rückgänge bei den Gewinnen sehen, erwartet ein Viertel der Betriebe einen Anstieg. 15 % rechnen sogar mit einem Verlust, was zeigt, dass die anhaltend schwierige Wirtschaftslage und die hohen Betriebskosten eine erhebliche Belastung darstellen. Diese Tendenzen zeigen, dass viele Hotels in der kommenden Saison mit einer Verschlechterung ihres finanziellen Ergebnisses rechnen und nur geringe Erwartungen an Gewinnsteigerungen haben.
Operatives Ergebnis ggü. Winter 23/24
Gewinn wird sich verringern
Gewinn wird steigen Ausgeglichen
Verlust wird steigen
Verlust wird sich verringern
Von Gewinn zu Verlust
Von Verlust zu Gewinn
Warte auf Hilfszahlungen
Mitarbeiter:innensuche bleibt Herausforderung
Rund 69 % der befragten Betriebe haben derzeit offene Stellen, insbesondere in den Bereichen Service und Küche, die besonders von dem Mangel betroffen sind. Positiv ist jedoch anzumerken, dass sich die Lage leicht entspannt hat: 31 % der Hotels berichten, dass die Mitarbeiter:innensuche einfacher geworden ist. Dennoch bleibt die Fachkräftesituation eine bedeutende Hürde.
Mitarbeiter:innen-Suche: leichte Verbesserung
Kredite und Investitionen: Knackpunkt Wettbewerbsfähigkeit
Neben den Herausforderungen in der Preisgestaltung und Mitarbeiter:innenverfügbarkeit hakt es auch bei der Finanzierung: Rund 45 % der befragten Hotels geben an, dass die Aufnahme von Krediten schwieriger bzw. deutlich schwieriger geworden ist, was in der aktuellen wirtschaftlichen Lage eine zusätzliche Belastung ist. Dennoch halten 51 % der Betriebe an ihren geplanten Investitionen fest, während 44 % diese zurückfahren müssen. Das spiegelt die Unsicherheit in der Branche wider und könnte sich langfristig auf die Modernisierung und Wettbewerbsfähigkeit der Betriebe und somit auf den ganzen Tourismusstandort Österreich auswirken.
Investitionen größtenteils planmäßig
Planmäßig Erhöht
Mehr Studien und Fakten zur österreichischen Hotellerie finden Sie unter oehv.at/studien
Diesmal steht der neue Kollektivvertrag für Hotel- und Gastgewerbe im Fokus unserer Rechtsrubrik. Er ist seit 01.11.2024 in Kraft und wirft einiges an Fragen auf.
Was sind die wichtigsten Vorteile des neuen KV für Arbeitgeber:innen?
• Der Kollektivvertrag gilt nun für ALLE Arbeitnehmer:innen, egal ob Arbeiter:innen, Angestellte, Praktikant:innen oder Lehrlinge (auch in nicht gastronomischen Berufen).
• Mit Teilzeitkräften kann nun eine Durchrechnung der Normalarbeitszeit über 26 Wochen bzw. sechs Monate und mit Jugendlichen über zwei Wochen vereinbart werden.
• Auch die Höchstarbeitszeit von 48 Stunden kann nun statt über 17 Wochen über 26 Wochen durchgerechnet werden.
• Für Pflichtpraktika sind alle zeitlichen Einschränkungen, wie zum Beispiel auf die Ferien, weggefallen.
• Die Probezeit ist für Arbeiter:innen und Angestellte automatisch ein Monat.
• Neu ist auch, dass die Kündigungstermine für Angestellte und Arbeiter:innen, aber auch für Arbeitgeberkündigung und Arbeitnehmerkündigung, vereinheitlicht worden sind. Sie sind mit jedem 15. oder Letzten eines Kalendermonats automatisch festgelegt und müssen nicht mehr im Arbeitsvertrag vereinbart werden.
Wie kann der Nachtzuschlag abgerechnet werden?
Alle Beschäftigten haben für die Arbeitszeit zwischen 00:00 Uhr und 06:00 Uhr einen Anspruch auf Nachtarbeitszuschlag, der im Folgemonat fällig ist. Dieser gliedert sich in folgende Abschnitte: von 00:00 Uhr bis 01:59 Uhr, von 02:00 Uhr bis 03:59 Uhr und von 04:00 Uhr bis 05:59 Uhr.
Pro Abschnitt gebührt ein Zuschlag von 9 Euro, für Arbeit in allen drei Abschnitten gebührt somit ein

Mag. Maria Wottawa ist Leiterin des ÖHV-Mitgliederservices und berät Sie in Rechtsfragen. Kontakt: mitglied@oehv.at
Zuschlag von 27 Euro. Bei einem Arbeitsbeginn frühestens um 05:00 Uhr gebührt ein Zuschlag von 4,50 Euro, bei einem Arbeitsbeginn frühestens um 05:30 Uhr gebührt kein Zuschlag.
Man kann auch vereinbaren, dass eine Überzahlung unter anderem den Nachtzuschlag abdeckt. Hier ein Formulierungsvorschlag (nicht Zutreffendes streichen):
Mit der Differenz zwischen dem monatlichen Istlohn und dem monatlichen kollektivvertraglichen Mindestlohn, der dem Grundlohn gemäß § 2g AVRAG entspricht, sind im Schnitt der Saison bzw. des Kalenderjahres sämtliche über das Überstundenpauschale hinaus geleisteten Überstunden, sämtliche Zulagen und Zuschläge, die sich aus dem anzuwendenden Kollektivvertrag ergeben, insbesondere die Fremdsprachenzulage und der Nachtarbeitszuschlag, sowie das Feiertagsarbeitsentgelt abgegolten.
Noch mehr FAQs und die wichtigsten Infos zum neuen KV finden Sie unter oehv.at/kollektivvertrag
Im Leben – auch im unternehmerischen – kommt es oft anders, als geplant. Verlieren Sie als Unternehmer:in beispielsweise durch einen Unfall oder eine Krankheit die Fähigkeit, in rechtlichen Angelegenheiten selbst zu entscheiden, hat dies auch schwerwiegende Folgen für Ihr Unternehmen. Denn die Alltagsgeschäfte sind weiterzuführen, wichtige Entscheidungen zu treffen oder rechtliche Schritte zu unternehmen.
In einer Vorsorgevollmacht können Sie klare Regelungen für derartige Notfälle schon im Vorhinein treffen. Dadurch bleibt Ihr Unternehmen auch bei Ihrer Abwesenheit handlungsfähig und Sie können verhindern, dass ein gerichtlicher Erwachsenenvertreter an Ihrer Stelle handelt.
Die Vorsorgevollmacht:
Ein Dokument der Selbstbestimmung
• Sie bestimmen, wer die Personen Ihres Vertrauens sind: Wählen Sie ein oder auch mehrere Vertrauenspersonen, die kompetent und mit dem nötigen Verständnis für die Geschäftsabläufe im besten Interesse des Unternehmens handelt.
• Sie bestimmen, welche Entscheidungen in Ihrem Namen getroffen werden dürfen: Legen Sie fest, für welche Aufgabengebiete jemand in Ihrer Abwesenheit zuständig sein soll, beispielsweise für Personal- oder vermögensrechtliche Angelegenheiten. Neben unternehmerischen Fragen können Sie auch bestimmen, wer für Sie über medizinische Fragen und ärztliche Behandlungen entscheiden soll.
• Sie bestimmen, ob und wann Sie die Vorsorgevollmacht widerrufen: Ein Widerruf ist jederzeit möglich.


Die Vorsorgevollmacht wird erst dann wirksam, wenn ein ärztliches Attest den Verlust der Entscheidungsfähigkeit bestätigt. Erlangen Sie Ihre Entscheidungsfähigkeit wieder, so wird sie auch wieder unwirksam. Damit sie im Ernstfall auch auffindbar ist, wird sie im Österreichischen Zentralen Vertretungsverzeichnis (ÖZVV) registriert.
Natürlich ist es nicht leicht, sich einzugestehen, dass wir alle nicht unsterblich und unverletzlich sind. Aber es ist doch besser, selbst die Weichen zu stellen und zu entscheiden, wer im Fall des Falles über einen und möglicherweise das Lebenswerk bestimmt.

MICHAEL UMFAHRER
Notar und Präsident der Österreichischen Notariatskammer
Die Vorsorgevollmacht ist für Unternehmer:innen nicht nur zum Schutz der persönlichen Interessen, sondern auch für den Fortbestand des Unternehmens in Krisenzeiten essentiell. Ihr:e Notar:in klärt Fragen gemeinsam mit Ihnen und errichtet eine individuelle Vorsorgevollmacht. Damit Ihr Lebenswerk Fortbestand hat.
Mehr Infos: ihr-notariat.at
Von stilvoll bis innovativ: 9 neu- oder wiedereröffnete Hotels, die in den letzten Monaten für Furore gesorgt haben.
• Eröffnung am 01.07.2024
• 98 Zimmer, davon 46 Suiten und 6 Chalets
• zwischen 180 und 250 Mitarbeiter:innen
Mit dem Rosewood Schloss Fuschl eröffnete im Juli der zweite Standort von Rosewood Hotels & Resorts in Österreich. Das sorgfältig restaurierte Jagdschloss aus dem 15. Jahrhundert wurde als authentischer alpenländischer Rückzugsort für anspruchsvolle Reisende konzipiert und beherbergt insgesamt 98 stilvoll eingerichtete Gästezimmer, darunter 46


• Neueröffnung am 01.12.2023
• 48 Zimmer und Suiten
• 60 Mitarbeiter:innen
exklusive Suiten und sechs gemütliche Chalets. Zum Resort gehört auch das 1.500 m² große AsayaSpa sowie sechs gastronomische Einrichtungen –von Schloss Restaurant und Bar über eine Vinothek mit Terrasse bis zum Sisi Teesalon.
rosewoodhotels.com/en/schloss-fuschl-salzburg


Nach umfassenden Renovierungsarbeiten bietet das historische Posthotel Taube heute 48 Zimmer und Suiten sowie vielseitige Gastronomie mit À-la-carte, Chef´s Table und Tages-Bar. Im Jagdhaus von 1453 erwarten Sie gesellige Runden und kulinarische Höhepunkte der Saison. Das neue Alpgues Haus beinhaltet auf über 400 m² Saunen, Dampfbäder,
kosmetische Behandlungen, Massagen und einen Fitnessbereich. Im Garten gibt es einen ganzjährig beheizten Pool und einen Hot Tub. Zwei hochwertige Sitzungsräume sind gegenüber der Taube im Haus Nescherina untergebracht.
posthotel-taube.at
• Eröffnung am 01.04.2024
• 196 Zimmer
• 80 Mitarbeiter:innen
Wen sprechen Sie an?
Neben neugierigen Reisenden und Kulturliebhaber:innen sprechen wir auch Kreativschaffende aus Design und Kunst an, die das stilvolle Ambiente und die inspirierende Atmosphäre zu schätzen wissen. Für Geschäftsreisende gibt es ein gut ausgestattetes Umfeld, in dem sie produktiv bleiben und Arbeit sowie Freizeit nahtlos verbinden können. Darüber hinaus ist das Hoxton Vienna der perfekte Rückzugsort für Paare und Freunde, die einen stilvollen und komfortablen Ort für ihre Wochenendausflüge suchen.
Wie sind Sie an den Umbau bzw. die Gestaltung des Hotels herangegangen?
BWM Designers & Architects haben 2019 einen Vorentwurf gemacht. Das erklärte Ziel von BWM war es, mit dem Bestand sorgsam umzugehen und die Struktur des Gebäudes weitestgehend zu erhalten – stets in enger Abstimmung mit dem Bundesdenkmalamt.
„Die Fassade erstrahlt im alten Glanz, dem Dachgeschoß wurde wieder die ursprüngliche Klarheit zurückgegeben, indem wir die Aufbauten der 80er Jahre zurückgenommen haben,“ so Markus Kaplan von BWM Designers & Architects.
Was war die größte Herausforderung?
Das in den 1950er Jahren geplante Bürogebäude im Stil der Nachkriegsmoderne wurde bis zuletzt als „Gewerbehaus“ genutzt und steht heute unter Denkmalschutz. Eine der Herausforderungen war es, Denkmal-, Personen- und Brandschutz in Einklang zu bringen. Darüber hinaus gab es eine große Unvorhersehbarkeit hinsichtlich Tragfähigkeit und Unterkonstruktion der Natursteinfassade. Hier war



Gefahr in Verzug und entsprechend wurde alles komplett erneuert.
Was sagen die Gäste?
Unsere Gäste sind sehr beeindruckt, was aus dem ehemaligen Gewerbehaus geschaffen wurde. Die Kombination aus alt und neu, die Qualität der Ausstattung, …

• Wiedereröffnung schrittweise von Mai bis August 2024
• 60 Zimmer und Suiten
• bis zu 170 Mitarbeiter:innen (Hotel Post & Das Traunsee)
Weltoffen – aber verwurzelt mit dem Salzkammergut, urbaner Lifestyle – aber inmitten des traditionellen Ortes Traunkirchen am Traunsee gelegen: Mit Weitblick und Respekt zur Heimat haben Monika und Wolfgang Gröller kürzlich ihr Hotel Post am See, welches seit 1950 im Besitz der Familie ist, wiedereröffnet. 21 Zimmer & Suiten wurden ergänzt, ein eigenes Stockwerk – die Belétage – ist

• Wiedereröffnung Ende August 2024
• 183 Zimmer und Suiten (132 Zimmer und Suiten wurden rundum erneuert)
• ca. 240 Mitarbeiter:innen
Insgesamt wurden über 23 Millionen Euro innerhalb der letzten 4 Jahre investiert, um Gästen und Team noch mehr Qualität und Komfort zu bieten. Die Summe floss in die Erneuerung zahlreicher Zimmer, Suiten und Balkone und in die Modernisierung der Hoteltherme. Lobby, Bar und Fassade erstrahlen in neuem Glanz, technisch wurde die Anlage auf den neuesten Stand gebracht. Zusätzlich wur-


nun Zentrum für gemeinsame Kulinarik-Erlebnisse.
Herzstück ist die Contemporary Bar, Frühstück gibt es bis zu Mittag und im Restaurant wird food sharing mit erstklassigen lokalen Zutaten zelebriert.
Neu ist auch das Rooftop Berg SPA im 6. Stock mit Infinity Pool, Sauna und Sunset Lounge mit Blick auf den Traunsee.
hotel-post-traunkirchen.at

den die Lebensquellen Naturwege – ausgewiesene Spazierwege auf dem vier Hektar großen Naturareal – innerhalb des Resorts errichtet. Weitere Maßnahmen folgten, um den Mitarbeitenden noch mehr Komfort zu bieten.
Das Heilthermen Resort Bad Waltersdorf setzt auf „Die Kraft der Natürlichkeit“. Natürliche Materialien wie Holz, Textilien, Naturfasern und Terrazzooptiken und helle Farben dominieren das Design und schaffen eine direkte Verbindung zur Natur. In den Zimmern und Suiten sorgen individuelle Schlafsysteme für tiefen, erholsamen Schlaf und innovative Infotainment-Systeme für beste Unterhaltung.
heiltherme.at/eröffnung
• Wiedereröffnung 19.07.2024
• 9 Einzelzimmer, 21 Doppelzimmer, 6 superior Doppelzimmer und 4 Suiten
• 30 Mitarbeiter:innen (inklusive der Gastgeber Natalie und Michael Läßer)
Was war die Motivation für den Umbau?
Nach 15 Jahren war es an der Zeit, das Hotel auf den neuesten Stand zu bringen und für die Zukunft vorzubereiten.
Welche Bereiche wurden umgebaut?
Es gibt eigentlich keinen Bereich, der nicht vom Umbau betroffen war. Von der Hotelzufahrt über Lobby, Rezeption, Bar und Restaurant bis hin zum Außenbereich. Die Zimmer wurden renoviert und vier neue Suiten kamen dazu – extra groß, mit Dampfdusche und Badewanne, gefülltem Weinkühlschrank u.v.m. Wir haben jetzt einen neuen Workout-Raum, einen Yoga-Raum und eine Fitness-Lounge mit Getränken und gesunden Snacks. Von hier geht es direkt zum neuen Sonnendeck mit ganzjährig beheiztem Relaxpool. Im Wellness-Bereich haben wir einen exklusiven Private Spa für Zwei ergänzt.
Nachhaltigkeit war uns immer schon sehr wichtig. Unsere PV-Anlage haben wir erweitert und nun auch eine Anlage auf dem neuen Carport. Wir können jetzt ein Drittel unseres Strombedarfs selbst produzieren. Seit dem Sommer 2024 gibt es zudem eine eigene Quelle zur Gartenbewässerung.
Wie sind Sie an den Umbau herangegangen?
Die ersten Überlegungen gab es bereits vor drei Jahren. Es folgten intensive Recherchen und ein Markenprozess. Der Architekt stand für uns bereits




fest und im Frühjahr 2023 starteten wir in die konkrete Planung. Umgebaut wurde schließlich von März bis Juli 2024.
Wie ist die (neue) Positionierung des Hauses?
Die Sonne bleibt ein Erwachsenenhotel. Mit dem Umbau steht aber der „Feel good“-Gedanke noch stärker im Zentrum. Wir bieten mehr Platz für weniger Gäste und rücken so die Qualität in den Mittelpunkt. Eine weitere Herzensangelegenheit ist für uns die Kulinarik – und edle Weine.
Was sagen die Gäste?
Der Plan geht auf! Die Gäste sind restlos begeistert.
sonnemellau.com
• Wiedereröffnung des Wälderhauses im Mai 2024
• 26 Zimmer und Suiten
• 40–50 Mitarbeiter:innen
Seit 1757 steht der Hirschen am Dorfplatz in Schwarzenberg. 2024 wurde – mit Peter und Pia Fetz in 10. Gastgebergeneration – eine neue Ära eingeläutet. Zum 3-Hauben-Restaurant gesellten sich ein Fermentationskeller samt eigenem Raum für die Prosciuttoreifung. Im großzügigen Garten entstand das ikonische Badehaus mit luftigen Ruheräumen, Saunen und 15-Meter-Pool. Unterirdisch ist es mit dem Wälderhaus verbunden: wo zuvor Seminare tagten, finden sich nun eine Bademantelbar, Turnraum und Tunraum (Meetings), darüber moderne Suiten in ruhiger Lage. Das Fine Hotel, Restaurant & Spa ist nun bereit für die nächsten 100 Jahre als „Showroom for the good Life.“
hotel-hirschen-bregenzerwald.at


• Wiedereröffnung im Mai 2024
• 124 Zimmer und 1 Beletage Suite
• ca. 40 Mitarbeiter:innen
Das traditionsreiche Hotel Astoria Wien im 1. Bezirk begrüßt nach 1,5 Jahren Umbau- und Renovierungszeit wieder Gäste aus aller Welt. Die historischen Art Deco Elemente des Hauses wurden behutsam revitalisiert und die vorhandenen Möbel im klassischen Wiener Stil restauriert.
Insgesamt investierte das VERKEHRSBUERO rund 15 Millionen Euro in den Umbau. Das Juwel der Wiener Gründerzeit bietet 124 neu gestaltete Zimmer, eine elegante Lobby, einen großen Frühstückssalon und die neue „Astoria Bar“, in der sich das
• Wiedereröffnung im Mai 2024
• 342 Zimmer, davon 18 Junior Suiten und 1 Suite
• ca. 110 Mitarbeiter:innen
Nach vier Jahren Pause und 18 Monaten Umbau wurde das erste Autograph Collection Hotel Österreichs eröffnet. Es bietet 342 Zimmer, eine 1.271 m² große Eventetage, einen Indoor-Pool und einen der größten Privatgärten Wiens. Das 1727 als Gartenpalais erbaute und später zur Militärreitschule umfunktionierte Gebäude verknüpft Tradition mit Kreativität.
Insgesamt flossen 45 Millionen Euro in den Umbau, darunter sieben Millionen für Nachhaltigkeitsmaßnahmen wie eine 1.650 m² große Photovoltaikanlage auf dem Dach, verbesserte Isolation, moderne Gebäudeleittechnik und Energie sparende Sensoren in allen Zimmern. Zudem gibt es zehn neue E-Ladestationen in der Parkgarage.




Wiener Publikum gleichermaßen wie Hotelgäste zu Hause fühlen sollen. Die neue 70 Quadratmeter große Beletage Suite ist mit einem romantischen Himmelbett und historischen Kaminen ausgestattet. Von den Balkonen der sieben Junior Suiten eröffnet sich der Blick auf die Kärntner Straße.
astoria-wien.com
Ob Küche, Etage oder Wellness – hohe Hygienestandards in allen Bereichen Ihres Hauses sind eine wesentliche Voraussetzung für die Gesundheit und das Wohlbefinden Ihrer Gäste und Mitarbeitenden. Wie steht’s um Ihre Maßnahmen? Verschaffen Sie sich Klarheit – mit einer Hygieneüberprüfung Objekt durch die hollu Anwendungstechnik.
Als Hotelier:in oder Gastronom:in tragen Sie die Verantwortung für die Gesundheit aller in Ihrem Haus. Dabei spielt die Einhaltung rechtlicher Vorschriften z. B. der HACCP-Vorgaben oder der Bäderhygieneverordnung eine bedeutende Rolle. Lassen Sie Ihre Hygienestandards von Zeit zu Zeit professionell überprüfen. So haben Sie die Gewissheit, dass Ihre Maßnahmen greifen und können etwaige Schwachstellen optimieren. Die Hygieneüberprüfung Objekt der hollu Anwendungstechnik umfasst neben der optischen auch eine mikrobiologische Kontrolle des Reinigungsergebnisses, um die vorhandenen Keimarten festzustellen. Falls Optimierungsbedarf besteht, werden Ihnen die nötigen Maßnahmen aufgezeigt. Am Ende erhalten Sie einen Prüfbericht mit der exakten Auswertung. Ihre Vorteile: Höchste Hygienequalität und Rechtsicherheit bei behördlichen Kontrollen.
Lassen Sie die Hygienemaßnahmen regelmäßig überprüfen, um gegebenenfalls Optimierungsmaßnahmen einzuleiten.

DI (FH) ANDREAS MARKSTEINER
Abteilungsleiter hollu Anwendungstechnik
TIPP: Melden Sie Ihr Team zum eintägigen hollu Akademie Seminar für eine sichere Küchenhygiene an. Das erworbene Fachwissen lässt sich sofort im Reinigungsalltag umsetzen.

Abklatschtests zeigen die Keimbelastung. Buchen Sie die Objekt-Hygieneüberprüfung, eine Serviceleistung der hollu Anwendungstechnik, und erhalten Sie Klarheit über die Wirksamkeit Ihrer Maßnahmen.
TIPP: Gleitreibwertmessung Ihrer Bodenbeläge!
Speziell in Spa- und Wellnessbereichen besteht die Gefahr, dass Personen ausrutschen und sich verletzen. Das hängt zum einen von der Art des Bodenbelags und zum anderen von der Reinigung ab. Auch hier unterstützen Sie die hollu Anwendungsspezialist:innen: Mit einer Gleitreibwertmessung werden die rutschhemmenden Eigenschaften Ihrer Böden ermittelt, um kritische Bereiche zu erkennen und Optimierungsmaßnahmen einzuleiten. Abschließend erhalten Sie einen Prüfbericht zur aktuellen Beschaffenheit Ihrer Böden. Damit haben Sie im Anlassfall einen Nachweis der Kontrolle für Behörden und Versicherungen. Erfahren Sie mehr auf:
www.hollu.com/service
MEHR INFORMATIONEN:
hollu Systemhygiene GmbH, hollu Campus 1, 6170 Zirl T: 00800 52800 900 (kostenlos aus A, I, CH und D) hollu.com
Die Gäste von morgen stellen neue Anforderungen, die Gastfreundschaft von heute muss sich neu erfinden – und die Hotellerie muss diesen Weg voller Mut und Kreativität gehen. „Neue Wege, neue Gäste.“ steht für zukunftsweisende Konzepte, die jüngere Generationen ansprechen und traditionelle Erwartungen überdenken. Flexibilität, Authentizität und die Bereitschaft zur Veränderung sind die Schlüssel, um im Wettbewerb zu bestehen und gleichzeitig ein hochwertiges, innovatives Gästeerlebnis zu bieten.
Besonders die Generationen Z und Alpha stehen im Fokus: Sie suchen nicht nur Unterkünfte, sondern erlebnisreiche, personalisierte Aufenthalte, die sich durch Nachhaltigkeit, Digitalisierung und eine starke Markenidentität auszeichnen. Innovative Plattformen und personalisierte, digitale Erlebnisse bringen neue Impulse, ebenso wie KI-gestützte Anwendungen und kreative Marketingansätze – von TikTok über Influencer-Marketing bis zu vernetzten digitalen Assistenten.
Was es dafür braucht? Eine Kultur, die Veränderung nicht scheut und Teams, die bereit sind, neue Wege zu beschreiten. Die Werte dieser neuen Gäste verlangen nach Hotelier:innen, die digitale Tools, ökologische Verantwortung und die Kunst der zwischenmenschlichen Begegnung nahtlos verknüpfen. Die nächsten Seiten bieten Ihnen einen kleinen Vorgeschmack, was Sie alles am ÖHV-Kongress in Innsbruck vom 22. bis zum 24. Jänner erwartet.
In diesem Sinne: Lassen Sie uns gemeinsam die Chancen nutzen, die „neue Wege“ uns eröffnen –und damit die Gäste von morgen gewinnen.
DR. MARKUS GRATZER
Generalsekretär der Österreichischen Hoteliervereinigung

Websline bietet die einzige Plattform, die alle wichtigen Hotelsysteme vereint: Buchung, Korrespondenz, Gutscheine, CRM und Newsletter. Die zentrale Lösung hebt Ihre Digitalisierung auf das nächste Level und maximiert die Effizienz.
Hotelsysteme – in jede Website integrierbar
Websline bietet eine zentrale Plattform, die alle wichtigen Hotelsysteme vereint – von IBE und Korrespondenzlösung über Newsletter bis hin zu CRM und Gutscheinverwaltung. Dank dieser umfassenden Lösung greifen alle Systeme nahtlos ineinander, sparen Zeit und reduzieren Kosten. Gäste profitieren von einem reibungslosen, personalisierten Service, da alle Leistungen zentral verwaltet werden. Hotels bündeln so alle Funktionen, die sonst durch verschiedene Softwarelösungen abgedeckt werden müssten – ein großer Vorteil für den Hotelbetrieb. Diese zentrale Lösung schafft Übersicht, stärkt die Zusammenarbeit im Hotel und optimiert die Gästekommunikation, was letztlich die Gästezufriedenheit erhöht.
Onlinemarketing – welchen Buchungsumsatz bringt Ihr Onlinemarketing?
Websline bringt das Onlinemarketing für Hotels auf das nächste Level: Mit integrierter Marketing-Automation ermöglicht die Plattform datenbasierte Kampagnen, die gezielt passende Gäste ansprechen.
Ob Performance-Marketing, SEO, Newsletter oder Social Media – jedes Hotel erhält eine individuelle Strategie, abgestimmt auf seine Ziele. Die Marketing-Suite misst den Buchungsumsatz jedes Kanals präzise und macht so den Kampagnenerfolg nachvollziehbar. Das ermöglicht eine effiziente Steuerung der Marketingausgaben und unterstützt Hotels nicht nur bei der Gewinnung neuer Gäste, sondern auch bei der langfristigen Bindung bestehender Kunden.
Dank datengetriebenem Marketing und klaren Einblicken in die Umsatzwirkung des Marketingbudgets wird die Strategie laufend optimiert – mit Fokus auf den tatsächlichen Buchungserfolg.

Die Agentur mit Mehrwert
Websline ist mehr als ein klassischer Dienstleister – es ist ein Partner für Hotels, die ihre Digitalisierung nachhaltig vorantreiben möchten. Mit modernster Technik und durchdachter Funktionalität integriert Websline alle wichtigen Systeme nahtlos, um Abläufe zu optimieren und das Gästeerlebnis zu verbessern. Die Systeme bieten nicht nur einen Mehrwert für Gäste, sondern entlasten auch Mitarbeitende und sparen Hotels Zeit und Kosten. Hotels können Prozesse effizient gestalten, die Kundenbindung stärken und gezielt ihren Umsatz steigern – digital, messbar und zukunftsorientiert.
KONTAKT
Franz Buchecker, Geschäftsführer Websline franz.buchecker@websline.com
Der technologische Fortschritt schreitet rasant voran. Und nur wer es versteht, Technologie gezielt für seine Ziele und sein Unternehmen einzusetzen, ist fit für die Zukunft. Was es dazu braucht, skizziert der Zukunftsforscher David Borst.

Die Welt dreht sich immer schneller und neue Technologien verändern unser Leben über Nacht. Künstliche Intelligenz, Quantencomputer, das Metaverse, Blockchain und Bioengineering sind nur einige Beispiele, die zeigen, wie rasant der technologische Fortschritt ist und warum viele den Überblick verlieren und sich verunsichert fühlen.
Warum die Zukunft Ihre größte Herausforderung ist
Die Zukunft ist die größte Herausforderung, der wir uns stellen müssen. Firmen scheitern, Kunden wechseln zur Konkurrenz, Investoren ziehen sich zurück – kein Umsatz, kein Unternehmen! Warum? Weil viele den Wandel nicht rechtzeitig bemerken. Die Frage ist daher: „Was muss ich heute tun, um die Kontrolle über meine Zukunft zurückzugewinnen?“
Um die Chancen der Zukunft zu nutzen, ist es entscheidend, aufstrebende Technologien zu verstehen.
Wir brauchen ein Zukunfts-Mindset
Uns fehlt das richtige Mindset für die Zukunft. Schon früh lernen wir, nichts falsch zu machen und kleine Verbesserungen anzustreben. Doch seien wir ehrlich: Ein Dieselmotor wird kein Elektromotor, indem wir den Verbrauch um zwei Prozent senken. Ihr Unternehmen wird kein Zukunftsunternehmen, indem Sie den Umsatz leicht steigern. Was Ihre Branche verändern könnte, ist eine völlig neue Technologie.
Der Reality Gap: Warum wir zurückbleiben könnten
Der Reality Gap ist die Lücke zwischen dem, was wir glauben, und der realen Entwicklung. Viele denken, Technologien entwickeln sich Schritt für Schritt –das ist ein Irrtum! Wir erleben einen exponentiellen Wandel. Die KI von OpenAI hat etwa 67.000-mal mehr Parameter als die Vorgängerversion – das ist wie der Unterschied zwischen einem einzelnen Buch und einer ganzen Bibliothek. Und bald hat jeder von uns die Intelligenz eines Concierge Services der besten Luxushotels auf seinem Mobiltelefon.
Quantencomputing ist ein weiteres Beispiel: Es bringt eine Rechenleistung, die klassische Computer nie erreichen könnten. Technologien wie Gen-Editing revolutionieren die Medizin und ermöglichen Behandlungen, die früher unvorstellbar waren. Diese Entwicklungen sind echte Quantensprünge, die unsere Welt verändern.
Das Metaverse entwickelt sich immer weiter und könnte eine ernsthafte Alternative zur echten Reise darstellen. Schon heute können berühmte Sehenswürdigkeiten wie die Chinesische Mauer und die Freiheitsstatue virtuell besucht werden. Während eine physische Reise zu diesen Zielen 7.600 USD kostet, beläuft sich der Preis für eine virtuelle Reise auf nur 2,50 USD.
Technologie als Chance, nicht als Bedrohung
Viele sehen Technologie als Bedrohung, die Arbeitsplätze oder ganze Branchen vernichtet. Laut einer Studie des Weltwirtschaftsforums könnten bis 2025 etwa 85 Millionen Arbeitsplätze wegfallen, doch gleichzeitig entstehen 97 Millionen neue Jobs. Wenn Sie Technologie mit einer klaren Mission verknüpfen, wird sie zu einem mächtigen Werkzeug: Prozesse werden beschleunigt, Qualität verbessert und Kosten gesenkt. Setzen Sie Technologie gezielt für Ihre Ziele ein.
Chancen für Unternehmen mit Mission
Die Demokratisierung der Technologie hat das Spielfeld ausgeglichen, denn Technologien, die einst nur großen Konzernen vorbehalten waren, sind jetzt für alle zugänglich. Kleinere Unternehmen mit einer klaren Mission können Großes erreichen. Eine starke Mission fördert Kreativität, zieht Menschen an, die dieselben Werte teilen, und schafft tiefere Beziehungen zu Kundinnen und Kunden. Wer gesellschaftliche Bedürfnisse adressiert, kann echten Wandel bewirken.
Die Lösung: Den Reality Gap schließen
Um den Reality Gap zu schließen, müssen Sie die Lücke zwischen dem, was Sie glauben zu wissen, und der Realität überbrücken. Wenn Sie die Prinzipien der technologischen Entwicklungen verstehen, können Sie diese im Unternehmen, im Team oder im Produkt anwenden, um in einer sich schnell verändernden Welt klar und effektiv zu handeln. Der Reality Gap wird geschlossen, und Ihr Unternehmen ist auf die Zukunft vorbereitet.

Das passiert, wenn der Reality Gap ignoriert wird – technologischer Wandel ist keine Option, sondern eine Notwendigkeit, um nicht zurückzufallen.
Das Mindset für die Zukunft
Stellen Sie sich vor, wie Ihre Mitarbeitenden nach einem inspirierenden Austausch über neue Möglichkeiten sprechen. Keine abstrakten Fachbegriffe, kein Techno-Geschwafel – nur klare Konzepte, die jeder versteht. Das richtige Verständnis von Technologie ermöglicht es Ihnen, sie gezielt zur Erreichung Ihrer Unternehmensziele zu nutzen. Die Prinzipien des Wandels werden verinnerlicht, und Ihre Mitarbeitenden entwickeln das richtige Mindset für die Zukunft.
Ihre Zukunft liegt in Ihren Händen. Setzen Sie jetzt die entscheidenden Schritte, um Ihr Unternehmen auf die Zukunft vorzubereiten. Jede Entscheidung, die Sie heute treffen, formt das Morgen Ihres Unternehmens.

AUTOR
David Borst Zukunftsforscher exponentiellerwandel.de
Die Zukunft des Tourismus ist digital, und KI wird dabei die zentrale Rolle schlechthin spielen. Unternehmen, die die Vorteile der KI nicht nutzen, werden ins Hintertreffen geraten –sagt Smartvisions-CEO Roman Egger.

Die Tourismusbranche steht an einem Wendepunkt, dessen Bedeutung kaum zu überschätzen ist. Künstliche Intelligenz (KI) ist dabei, die Grundlagen des Tourismus grundlegend zu verändern und es ist meine feste Überzeugung, dass wir an der Schwelle zu einer Transformation stehen, die in ihrer Tragweite mit der Erfindung des Buchdrucks oder der industriellen Revolution vergleichbar ist.
In einem bemerkenswerten Interview mit dem USFernsehmagazin „60 Minutes“ behauptete GoogleCEO Sundar Pichai, die Entwicklung der KI übertreffe sogar bedeutende technologische Fortschritte wie die Elektrizität. Pichai sagte hierzu: „Es geht um das Wesen der Intelligenz an sich.“ Auch Investitionsrunden wie jene von OpenAI, die kürzlich erst 6,6 Mrd. USD in die Firmenkasse spülte, zeigen, dass die Wirtschaft das Thema KI nicht als Hype sondern als ernstzunehmende technologische Transformation ansieht.
Was bedeutet das für uns?
Künstliche Intelligenz (KI) wird nicht nur unsere Arbeitsprozesse, sondern auch unser Denken und unsere Geschäftsmodelle tiefgreifend verändern. Ähnlich wie bei der Einführung des Internets stehen wir vor der Herausforderung, unsere Prozesse im Tourismus grundlegend zu überdenken: Wir werden verändertes Kundenverhalten erleben, neue Kommunikationsformen, die uns zu einer Neuausrichtung des Marketings zwingen. Bisher unbekannte Berufsbilder werden entstehen, während sich bestehende Jobprofile drastisch wandeln werden. Interne Abläufe und Arbeitsweisen müssen hinterfragt und an die neuen Möglichkeiten angepasst werden. Der Umgang mit Informationen und Daten wird sich drastisch ändern. Dies reicht von der einfachen Datenverarbeitung bis hin zu neuen Prinzipien der Entscheidungsfindung, die vor allem datengetrieben sein wird.
Im Vergleich zu den Umwälzungen durch das Internet werden diese Veränderungen noch tiefgreifender sein und vor allem mit atemberaubender Geschwindigkeit eintreten.

Künstliche Intelligenz (KI) ist eine disruptive Technologie, deren volles Potenzial wir aktuell nur schwer abschätzen können. Die Geschwindigkeit und das Ausmaß der Veränderungen stellen uns vor massive Herausforderungen: Wie können wir KI gezielt nutzen, um echten Mehrwert zu schaffen? Die Vielzahl an Werkzeugen und Möglichkeiten ist beeindruckend, doch ebenso groß ist der Bedarf an Kompetenz und Fachwissen, um diese Technologie erfolgreich einzusetzen.
Den Wandel aktiv gestalten
Ein entscheidender Erfolgsfaktor wird sein, unsere Mitarbeiter:innen frühzeitig in den Prozess der KIIntegration einzubeziehen und sie in die Lage zu versetzen, aktiv mit dieser Technologie zu arbeiten. KI kann unsere Kreativität, Produktivität und Kosteneffizienz erheblich steigern – vorausgesetzt, sie wird sinnvoll eingesetzt. Unsere Teams müssen den konkreten Nutzen der KI verstehen, etwa durch Zeitersparnis bei Routineaufgaben. Dieses Verständnis kann jedoch nur entstehen, wenn Mitarbeitende die Möglichkeit haben, KI selbst auszuprobieren, praktische Erfahrungen zu sammeln und den daraus resultierenden Mehrwert selbst zu erleben.
Daher ist es unerlässlich, in Schulungen und Weiterbildungsprogramme zu investieren. Sowohl externe Workshops als auch interne Fortbildungen sind notwendig, um Plattformen für den Wissensaustausch zu schaffen. Zwei Punkte halte ich in dieser Phase für besonders entscheidend: Erstens müssen Sie Ressourcen freisetzen, damit Ihre Teams KI effektiv nutzen können. Das betrifft nicht nur finanzielle Mittel für die Anschaffung, Nutzung und Evaluierung von Tools, sondern vor allem Zeitressourcen für Ihre Mitarbeiter:innen, damit sie die nötigen Erfahrungen sammeln können.
Der zweite, eng damit verbundene Faktor ist die Schaffung von Raum für den Erfahrungsaustausch. Etablieren Sie sowohl interne Wissensnetzwerke als auch Kooperationen mit Ihren Partnern, denn die Veränderungen werden in einer Geschwindigkeit eintreten, die schwer zu bewältigen ist. Die Bereitschaft, Erfahrungen zu teilen und voneinander zu lernen – möglichst in einem definierten und strukturierten Rahmen – wird entscheidend dafür sein, ob Sie den Anschluss halten oder zurückfallen.
KI ist Chefsache!
Denken Sie daran, Künstliche Intelligenz (KI) ist weit mehr als nur ein Werkzeug zur Generierung von Texten, Bildern oder Marketinginhalten. Sie muss als strategisches Instrument verstanden werden, das in alle Unternehmensbereiche integriert wird. Führungskräfte haben die Verantwortung, den Einsatz von KI zu steuern und klare Richtlinien festzulegen, die den Umgang mit dieser Technologie regeln. Nur so kann sichergestellt werden, dass KI verantwortungsvoll und gewinnbringend eingesetzt wird. Erklären sie KI zur Chefsache!
Ich bin überzeugt, dass jene Unternehmen, die den Mut haben, die Herausforderungen der KI-Integration anzugehen, nicht nur überleben werden, sondern in einem neu definierten Markt erfolgreich sein werden. Verweigern ist definitiv keine Option!

DER AUTOR
Prof. Dr. Dr. Roman Egger, CEO von Smartvisions.at und Ass. Prof. an der Modul Universität, Wien.
WEGE, NEUE GÄSTE.
Tourismusmarketing im Umbruch: Österreich und Deutschland in der Krise – wo kommen die Gäste der Zukunft her und wie können sie gewonnen werden? Eine Analyse von Tourismusberater Richard Bauer.
Die Nachfrage in den österreichischen Hotels ist unmittelbar mit der Wirtschaftsentwicklung der Herkunftsländer verbunden. Eine florierende Wirtschaft führt zu steigenden Einkommen und deutlich höherer Bereitschaft zu vereisen. Eine stagnierende Wirtschaft bewirkt gedämpfte Stimmung. Nicht notwendige Ausgaben werden verschoben oder überhaupt nicht getätigt.
Der aktuelle WIFO-Konjunkturtest zeigt mehrheitlich skeptische Konjunkturausblicke.1 Eine Besserung der Lage ist nicht in Sicht. Es droht die längste Rezession der letzten 25 Jahre.2 In Deutschland ist es nicht besser. Das Geschäftsklima hat sich weiter eingetrübt. Die deutsche Wirtschaft dürfte in ihrer Schwächephase verharren.3
Was bedeutet dies für die Hotel-Nachfrage 2025?
Österreich ist stark von Urlauber:innen aus Deutschland und Österreich abhängig. Sie machen rund 64 % aller Nächtigungen aus.4 Es kommen zwar nach wie vor viele Gäste aus diesen Märkten, sie geben aber immer weniger aus. Deutschland liegt bei den Tagesausgaben aller Herkunftsmärkte mittlerweile an vorletzter Stelle.
Ein weiterer Nachteil ist, dass Österreich als Zweitoder Drittreiseziel positioniert ist. Der Haupturlaub – das ist in der Regel ein Badeurlaub am Meer –bleibt Fixpunkt. Aber Kurzreisen, verlängerte Wochenenden usw. können ohne große Einschritte aufgeschoben bzw. ausgelassen werden. Und das trifft in erster Linie Österreichs Hotellerie.

Was ist zu tun?
Um gut aufgestellt zu sein, braucht es eine
Neuausrichtung des Hotelmarketings:
• neue, für die Zukunft wachstumsstarke Märkte aufbauen
• kaufkräftige Schichten mit den richtigen Produkten und Botschaften ansprechen
Wo liegen die Wachstumsmärkte für die Hotellerie?
Eine Vertriebslandkarte zeigt anhand von realen Daten: wo liegen Wachstumsmärkte und wie viel geben die Gäste pro Tag aus (ohne An- und Abreise).5 Es zeigt sich beispielsweise:
Die USA haben sich zum wichtigsten Fernmarkt entwickelt. Die Amerikaner:innen sind sehr ausgabefreudig (323 Euro pro Person und Tag). Durch das hohe Reiseinteresse (auch bei jüngeren Zielgruppen) und die gute Fluganbindung stehen die Chancen für Österreichs 4*/5*-Hotellerie für diesen Markt sehr gut.
Die Nächtigungen aus Tschechien und Polen liegen auf einem Allzeithoch. Tschechien ist der viertwichtigste ausländische Herkunftsmarkt und die 37 Mio. Polen sind sehr reisefreudig. Mit 158 Euro und 161 Euro geben diese Gäste pro Tag mehr aus als Urlauber:innen aus Deutschland. Neben dem Winter bietet der Sommer in der Kombination von Wandern, Rad, Mountainbike und Baden im See neue Chancen für die österreichischen Hotels.
1 WIFO Konjunkturtest 10/2024 | 2 WIFO Monatsberichte, Heft 09/2024 | 3 Deutsches Bundesministerium für Wirtschaft und Klimaschutz: Die wirtschaftliche Lage in Deutschland im Oktober 2024 | 4 Statistik Austria, Nächtigungen 2023 Gesamtjahr | 5 Daten zu Nächtigungen und Marktanteilen von der Statistik Austria, Daten zu den Tagesausgaben von der Österreich Werbung


Schweiz, Großbritannien, Italien erleben eine Renaissance (Wachstumsraten zwischen 17 % und 20 %). Für die gehobene Hotellerie gibt es mit der Kombination aus einzigartigen kulinarischen Erlebnissen, spektakulären Naturattraktionen und dem Besuch führender Sehenswürdigkeiten wie die Austrian Leading Sights gute Potenziale.
Markt- und Themen-Potenziale für die österreichische Hotellerie 2025
• USA: Eintauchen in die Lebenskultur einer Stadt in Kombination mit Veranstaltungen, Sehenswürdigkeiten, Entdecken neuer Orte sowie Skiurlaub
• Großbritannien: Bergerlebnis mit Kulinarik, Städte, Ski
• Tschechien: Sehr sportliche Winter- und Sommerangebote mit Schwerpunkt Rad/Berg
• Schweiz: Kombinationen aus Wellness, Kulinarik und Sporterlebnissen, Städte, Ski
• Polen und Slowakei: Sportliche Winterangebote und Familiensommer in den Bergen und an den Seen
• Belgien: Naturerlebnisse kombiniert mit typischer Kulinarik, Ski
• Italien, Spanien und Frankreich: Städtereisen und Attraktionen wie Adventmärkte, gemütlichere Naturerlebnisse kombiniert mit Kultur
• Schweden, Dänemark: Familienurlaub in den Bergen, Ski

Richard Bauer
Die Gäste in Österreich, Deutschland und Niederlande wünschen sich neue Inspirationen. Die Praxis zeigt, dass gut ausgearbeitete Reiseanlässe sofort hohe Aufmerksamkeit bewirken und zu neuen Buchungen führen.
5 Schritte für die Neuausrichtung des Hotelmarketings
Markt-Chancen erkennen: Vergleich der Nächtigungen mit dem Ort/der Region. Damit ist ersichtlich, wo Potenziale liegen.
Themenabgleich: Anhand der Sehnsüchte der Gäste ist ableitbar, ob man die richtigen Themen bieten kann.
Produkte anpassen: Gäste haben unterschiedliche Erwartungen, z. B. steht für Sommergäste aus Italien die Gemütlichkeit an erster Stelle, für Gäste aus Tschechien geht es dagegen um das sportliche Erlebnis.
Marktauftritt: Übersetzung der Produkte in Bild, Text und Video und Reiseanlässe vermitteln (bewirkt Buchungen)
Marketing-Review: Vergleich der Buchungen in Relation zum eingesetzten
Die Tourismusberatung Richard Bauer bietet maßgeschneiderte Lösungen für Zukunftsfragen der Tourismus- und Freizeitwirtschaft. richardbauer.at
Wer die eigenen Gäste perfekt ansprechen und bespielen möchte, muss umdenken und neue Wege in der Segmentierung gehen: Zielgruppen sind tot, es lebe der Stil! Jakob Ledermann und Leon Hetzer von philoneos über Rockstar-Monarchen und verstaubtes Schubladen-Denken.

Ein Witz – oder besser: ein Gedankenspiel: King Charles und Ozzy Osbourne treffen sich auf einen Drink in der Hotel-Bar…
Klingt wie der Anfang eines schlechten Witzes, oder? Ist aber ein nettes Gedankenspiel, um die Relevanz von Stilgruppen und die Probleme von Zielgruppen zu veranschaulichen – lassen Sie uns das mal gemeinsam durchspielen: Schauen wir uns die beiden Herren im Detail an. Der eine Monarch, eher konservativ geprägt. Der andere Rockstar, Heavy Metal Hard Rock. Müssten wir Gegensätze definieren, könnten wir die beiden leicht verwenden.
Doch warten Sie – beide sind männlich, 1948 geboren, aufgewachsen in Großbritannien. Beide zweimal verheiratet, haben zwei Kinder. Beide leben in einem Schloss, sind wohlhabend und verbringen ihre Winterferien gerne in den Alpen.
Hätte ich Sie darum gebeten, eine Zielgruppe in alter Manier zu definieren, hätten Sie sicherlich genau solche Aspekte zum Definieren der Zielgruppe verwendet – und die beiden Herren in ein und dieselbe
Zielgruppe gepackt. Ein fataler Fehler, denn unterschiedlicher können wohl Charaktere und damit verbundene Anforderungen an die Eigenschaften eines Produktes oder einer Dienstleistung nicht sein.
Zielgruppen also tot, was nun?
Lassen Sie uns mit dem verstaubten SchubladenDenken aufhören und Menschen nicht mehr in Zielgruppen aufgrund ihrer vermeintlich beschreibenden Attribute kategorisieren. Die klassische Zielgruppensegmentierung nach Alter, Einkommen und Familienstand hat ausgedient. In einer Zeit, in der Lebensstile und Wertevorstellungen die Kaufentscheidungen stärker prägen als demografische Merkmale, müssen auch Hotelier:innen umdenken.
Der Schlüssel zum Erfolg liegt in der Entwicklung von „Stilgruppen“ – einem innovativen Ansatz, der Verhaltensweisen, Präferenzen und Lebensstile in den Mittelpunkt rückt.
Der Stilgruppen-Ansatz basiert auf der „Segmentation Bases“-Theorie aus dem Marketing. Dieser Ansatz nutzt vier Segmentierungs-Felder, um den oft unübersichtlichen Gesamtmarkt in überschaubare, homogene Teilmärkte zu unterteilen: Demografie, Geografie, Psychografie und Verhalten
Theoretisch klingt das gut, schauen wir uns das ganze mal exemplarisch in der Praxis an:
Stellen Sie sich vor, Sie betreiben ein Sportgeschäft. Würden Sie einem 70-jährigen Rentner und einer 25-jährigen Leistungssportlerin die gleichen Produkte empfehlen? Wahrscheinlich nicht. Hier kommen demografische Merkmale ins Spiel: Alter, Geschlecht oder Einkommen beeinflussen Kaufentscheidungen maßgeblich. Doch das ist nur der Anfang. Geografische Faktoren bestimmen beispielsweise, ob Winterkleidung in einer Region überhaupt Sinn macht – in Dubai würde sich der Verkauf von Skianzügen vermutlich schwierig gestalten.
Besonders spannend wird es bei der psychografischen Segmentierung. Hier geht es um die „weichen“ Faktoren: Welchen Lebensstil pflegen die Kundinnen und Kunden? Welche Werte sind ihnen wichtig? Ist Nachhaltigkeit ein Kaufargument oder zählt nur der Preis? Diese Erkenntnisse werden durch verhaltensorientierte Merkmale ergänzt – also das tatsächliche Kaufverhalten. Manche Kunden sind treue Markenfans, andere springen bei jedem Sonderangebot zur Konkurrenz.
Lead User als Innovationstreiber
Unserem Ziel kommen wir immer näher, wenn wir jetzt noch in unserer kundenzentrierten Manier den Lead-User-Ansatz integrieren. Lead User sind innovative Nutzer:innen, die Bedürfnisse bereits Jahre vor dem Massenmarkt entwickeln und oft eigene Lösungen kreieren, weshalb sie für Unternehmen wertvolle Innovationspartner:innen darstellen. Diese Gäste sind ihrer Zeit voraus und zeigen schon heute, was morgen zum Standard wird. Wer seine Lead User ernst nimmt, kann Innovationszyklen antizipieren und sich rechtzeitig positionieren.
Ein Beispiel: Vor einigen Jahren forderten einzelne Geschäftsreisende flexible Check-in-Zeiten und Mobile Keys – heute ist dies vielerorts der altbekannte Standard.
PRAXISTIPPS für Hotelier:innen –wie kommen wir zu Stilgruppen?
Identifizierung von Stilgruppen
• Analysieren Sie Buchungs- und Nutzungsmuster
• Führen Sie qualitative Interviews mit Stammgästen
• Beobachten Sie Trends in Ihren Online-Bewertungen
Produkt- und Serviceanpassung
• Entwickeln Sie flexible Module
• Schaffen Sie personalisierbare Basis-Angebote
• Denken Sie in Erlebnissen statt in Zimmerkategorien
Kommunikation
• Sprechen Sie Lebensstile statt Altersgruppen an
• Nutzen Sie die Sprache und Kanäle Ihrer Stilgruppen
• Schaffen Sie authentische Berührungspunkte
Die Entwicklung von Zielgruppen zu Stilgruppen ist kein einmaliger Prozess, sondern eine kontinuierliche Anpassung an sich verändernde Gästebedürfnisse. Erfolgreiche Hotels der Zukunft werden nicht mehr in starren Kategorien denken, sondern flexible Konzepte entwickeln, die verschiedene Stilgruppen ansprechen.
TIPP ZUM THEMA:
Workshop „Customer Centricity –Talk to your future guests“ am ÖHV-Kongress 2025!


am ÖHV-Kongress 2025!
Jakob Ledermann Senior Consultant und Co-Creator bei philoneos GmbH, Speaker und Zukunftsgestalter
Leon Hetzer Consultant und Co-Creator bei philoneos GmbH, AIxperte und professioneller Nerd
Digitalisierung, Nachhaltigkeit und Authentizität sind die Schlüssel, um die Ansprüche der Gen Z zu erfüllen. So eine aktuelle Studie der ÖHV zur „Zukunft der Hotellerie aus Sicht der Gen Z“. Studienleiter Vladimir Preveden mit den Details.


Die Studie zeigt, dass die Gen Z, geboren zwischen 1996 und 2012, eine wachsende Bedeutung in der Reisebranche aufweist. Um langfristig erfolgreich zu bleiben, ist es für die Hotellerie daher unerlässlich, Strategien, Angebote und Kommunikation an diese Zielgruppe anzupassen. Dazu fünf wichtige Erkenntnisse:
Nachhaltigkeit und Ethik:
Gen Z achtet stark auf umweltbewusste und ethische Geschäftspraktiken. 60 % dieser Generation möchten nachhaltig reisen und sind bereit, dafür zu bezahlen. Unternehmen, die transparent und glaubwürdig nachhaltige Maßnahmen umsetzen, gewinnen das Vertrauen und die Loyalität dieser Zielgruppe.
Social Media und digitale Inspiration:
Gen Z lässt sich bei ihrer Reiseplanung vor allem von digitalen Kanälen und sozialen Netzwerken wie Instagram und TikTok inspirieren. Fast 92 % von ihnen gaben an, dass ihre letzte Reise durch Social Media beeinflusst wurde. Authentisches Storytelling und Influencer-Marketing spielen hierbei eine entscheidende Rolle.
Als erste vollständig digital geprägte Generation erwartet Gen Z, dass das gesamte Reiseerlebnis digital unterstützt wird. Von der Buchung bis hin zum Check-in und Check-out und bis zur nächsten Buchung möchten sie möglichst kontaktlos und bequem alles über digitale Tools abwickeln. Technologien wie mobile Check-ins, digitale Zimmerschlüssel und wahrhaftig personalisierte Angebote auf Basis von Datenanalysen gehören (bereits) zu den Grundanforderungen.
Personalisierung:
Gen Z bevorzugt maßgeschneiderte Erlebnisse. Mit künstlicher Intelligenz und Big Data können Hotels individuelle Reiseangebote erstellen, die sich an den Vorlieben der Gäste orientieren. Personalisierte Empfehlungen und Services schaffen eine engere Bindung zur Marke und steigern die Zufriedenheit. Datenexpertise und Datensouveränität werden zum Muss für Hotelier:innen, die erfolgreich bleiben wollen.
Budgetbewusst, aber erlebnisorientiert:
Trotz ihres preisbewussten Verhaltens ist die Gen Z bereit, für besondere und authentische Erlebnisse zu zahlen. Vor allem günstigere Unterkunftsarten sind beliebt, solange sie ein einzigartiges Erlebnis bieten.
Ein besonders spannender Aspekt ist die bedeutende Rolle der Digitalisierung in der Hotellerie für die Gen Z. Diese Generation erwartet, dass Technologien nicht nur unterstützend, sondern zentraler Bestandteil des Erlebnisses sind. Dabei können wir schon zwei Aspekte hervorheben.
Technologische Integration: Die Gen Z erwartet durchgehend digitale Erlebnisse – von der Buchung über den Aufenthalt bis zur Kommunikation nach dem Aufenthalt.
Personalisierung durch Daten: Mit künstlicher Intelligenz können Hotels personalisierte Erlebnisse schaffen, die auf den Präferenzen der Gäste basieren. Dies kann in Form von Empfehlungen zu Aktivitäten oder maßgeschneiderten Angeboten erfolgen.
Insgesamt zeigt sich, dass die Digitalisierung weit mehr ist als nur ein zusätzlicher Service – sie ist, gemeinsam mit dem Thema Nachhaltigkeit, der Schlüssel, um die Ansprüche von Gen Z zu erfüllen. Hotels, die in innovative digitale und nachhaltige Lösungen investieren und diese in ihren Service integrieren, werden langfristig profitieren.

DER AUTOR
Vladimir Preveden Managing Director VP Strategy
Wie können Hotels wichtige Investitionen tätigen, wenn das Budget knapp ist? HoxamiGeschäftsführer Gerhard Sperrer erklärt, wie Ausgaben für Energie, Betriebsmittel oder für Renovierungen ohne Fremdmittel mit leeren Zimmern finanziert werden können.
Wie helfen hoxami SaleSolutions leerstehende Zimmer in einen Zusatzertrag zu verwandeln?
Ganz einfach: Mit Cash & Invest füllen wir Zimmer, die sonst leer bleiben. Das Hotel bestimmt, wann ein Kunde anreisen darf – so wird der Ertrag gesteigert und die Auslastung optimiert!
Wie genau funktioniert die Finanzierung über hoxami Cash & Invest?
Unsere Lösung bietet zwei Optionen: Im CashModell bezahlen wir Zimmerkontingente direkt an die Hotels. Beim Invest-Modell bezahlen wir die Rechnungen von Hotel-Lieferanten. Rechnet ein Hotel korrekterweise mit den Grenzkosten, ergibt sich ein zusätzlicher Effekt in Form eines Extrarabatts auf die Investition.
Warum ist Cash & Invest eine Win-win-Situation für Hotels und Zulieferbetriebe?
Hotels investieren ohne Fremdkapital bzw. Rechnungen von Hotel-Lieferanten werden sofort bezahlt. Das System funktioniert seit Jahren sehr gut. Wir arbeiten mit vielen Anbietern – von Hoteleinrichtungen, PV-Anlagen, Ladeinfrastruktur bis hin zu Marketingdienstleistungen. Und auch bei den Hotels wird die Liste täglich länger.
Was versteckt sich hinter dem hoxami Partner-Pool für Hotels?
Wir sind gerade dabei einen Partner-Pool online einzurichten, in dem Hotels viele innovative und hochwertige Zulieferbetriebe finden werden, bei denen sie mit ihren leeren Zimmern bezahlen können.

KONTAKT
Gerhard Sperrer, Geschäftsführer info@hoxami.com hoxami.com
Wer sich auf die zukünftigen Gäste vorbereiten möchte, sollte am besten heute schon damit beginnen, denn die nächste Generation kommt schneller als gedacht. Und man sollte sich anschnallen: Ok, Boomer! Warum die Zoomers die Hotellerie auf den Kopf stellen werden. Ein Beitrag von Zukunftsgestalter Jakob Ledermann.

Während viele Betriebe noch damit beschäftigt sind, ihre Angebote auf die Millennials auszurichten, steht die nächste Generation bereits vor der Tür und klopft an – und sie bringt völlig neue Anforderungen mit sich. Die zwischen 1997 und 2012 geborene Generation Z entwickelt sich zu einem wichtigen Wirtschaftsfaktor, der die Tourismus- und Hospitality-Branche nachhaltig verändern wird.
Wirtschaftliche Bedeutung unterschätzt
Nicht nur ist die Generation Z die größte Generation der Geschichte und macht derzeit ca. 25 % der Weltbevölkerung aus – anders als ihre Vorgänger verfügt die Gen Z bereits in jungen Jahren über beachtliche Kaufkraft und gibt schon jetzt pro Kopf mehr aus als jede andere Generation im gleichen Alter. Dabei geht es längst nicht mehr nur um Taschengeld: Es wird erwartet, dass die Kaufkraft der Generation Z bis zum Jahr 2030 auf 12 Billionen US-Dollar ansteigt (NielsenIQ, Spend Z Report). Diese Generation wird einen erheblichen wirtschaftlichen Einfluss haben und mit ihren Anforderungen so einige Branchen umkrempeln.
Authentizität schlägt Luxus
Die Werte der Gen Z unterscheiden sich von denen vorheriger Generationen. Während Millennials noch stark auf Erlebnisse und Selbstoptimierung setzen, sucht die Gen Z nach Authentizität und Nachhaltigkeit. Wichtig dabei: Hotelsterne ersetzen keine Nachhaltigkeitslabel – 73 % würden sich eher für eine Unterkunft entscheiden, wenn die Unterkunft nachhaltige Praktiken anwendet (Deloitte, The Hotel of the Future).
Mobile First war gestern
Die Gen Z denkt nicht in Kategorien wie „online“ und „offline“ – sie lebt in einer verschmolzenen Realität. Während Millennials das Smartphone als wichtiges Tool nutzen, ist es für die Gen Z eine natürliche Erweiterung ihrer selbst. Das bedeutet für Hotelier:innen: Ein responsives Design der Website ist nicht mehr ausreichend. Die Customer Journey muss von Grund auf digital gedacht werden – von der Inspiration über die Buchung bis zum Check-out.
Personalisierung neu gedacht
Interessanterweise lehnt die Gen Z klassische Formen der Personalisierung häufig ab. Stattdessen erwartet sie intuitive Systeme, die ihre Bedürfnisse antizipieren, ohne dabei aufdringlich zu wirken. Ein Beispiel: Anstatt nach Präferenzen zu fragen, sollten Hotels Technologien in Verbindung mit KI zur Interpretation einsetzen, die aus dem Verhalten der Gäste lernen und subtil passende Angebote unterbreiten.
Die neue Arbeitswelt als Chance
Remote Work und hybride Arbeitsmodelle sind für diese Generation selbstverständlich. Hotels können davon profitieren, indem sie sich als „Third Space“ zwischen Büro und Home-Office positionieren. Moderne Workspaces, hochwertige Videokonferenz-Ausstattung und flexible Buchungsmodelle werden zu entscheidenden Erfolgsfaktoren – das „Bleisure“-Konzept erlebt durch die Gen Z einen regelrechten Boom.
Social Media: Mehr als Marketing
Die Generation Z wird den Tourismus grundlegend verändern. Für Hotelier:innen ergeben sich daraus konkrete Handlungsfelder. Betriebe, die jetzt die Weichen richtig stellen, können von diesem Wandel profitieren. Dabei geht es nicht darum, jeden Trend mitzumachen, sondern die eigene Authentizität mit den Bedürfnissen dieser wichtigen Generation in Einklang zu bringen.
Was bedeutet das denn jetzt alles für Hotelier:innen?
Und wo soll man anfangen?
#takeitseriously:
Oft werden die Zoomer von den Boomern „belächelt“ und aufgrund ihrer Andersartigkeit abgetan. Das sind Ihre Gäste der Zukunft, nehmen Sie sie ernst, sonst werden sie nicht zu Ihnen kommen.
#trytounderstand:
Auf den ersten Blick wirken manche Eigenschaften und Anforderungen der Gen Z eigenartig – doch das meiste ergibt bei genauerer Betrachtung Sinn. Wenn wir uns bemühen, die Gen Z wirklich zu verstehen – profitieren wir dann vielleicht nicht nur geschäftlich, sondern auch privat?
#talktoyourfutureguests:
Weniger übereinander, mehr miteinander reden. Das beste Rezept für eine erfolgreiche Adressierung der Gen Z ist mit ihnen zu reden – und relevante Rückfragen zu stellen. Entwickeln Sie gemeinsam mit dieser bedeutenden Generation die Hotellerie der Zukunft.
Für die Gen Z sind soziale Medien nicht nur Informationsquellen, sondern primäre Entscheidungsplattformen. Dabei geht es weniger um perfekt inszenierte Hotelfotos, sondern um authentische Einblicke und echte Erfahrungen. Ein bemerkenswerter Trend: 82 % vertrauen den Empfehlungen von Mikro-Influencern (User Generated Content) mehr als professionellem Hotelmarketing (Keywordseverywhere, UGC-Stats). Hotels müssen lernen, ihre eigenen Gäste als Markenbotschafter:innen zu aktivieren. NEUE WEGE, NEUE GÄSTE.

DER AUTOR
Jakob Ledermann, Senior Consultant und Co-Creator bei philoneos GmbH, Speaker und Zukunftsgestalter

Die Digitalisierung hat Millionen Menschen zu Menschen mit besonderen Bedürfnissen gemacht. Die meisten werden ohne WLAN aggressiv. Eine wachsende Minderheit sucht Entspannung im digitalen Entzug. Fluch oder Segen? Beides – meint Digialisierungs-Expertin Anitra Eggler.
Als ich in den Infinity-Pool des „Worlds Best Hotel Spa 2024“ sprang, fiel mir auf, dass ich die Einzige war, die kein aufwändiges Make-up, keine Föhnfrisur und kein Handy trug.
Kaum hatte ich mich in einen kleinen Whirlpool gelegt, drängelte sich eine vierköpfige chinesische Familie dazu. Die Familie war mit Selfiesticks bewaffnet und begann ohne Vorwarnung Gruppenselfies zu schießen.
Entspannen kann heutzutage anstrengend sein …
Ich äußerte den Wunsch, nicht fotografiert zu werden, was aufgrund der Enge im Whirlpool unmöglich war. Mein Wunsch wurde bissig mit „Die happy!!!“ beantwortet, auf gut Deutsch: „Zieh Leine und stirb glücklich, du Spaßbremse!“
Dieses Erlebnis hat meinen Umgang mit Smartphone-Zombies evolutioniert. Ich reagiere inzwischen gelassen auf Menschen, die mit Föhnfrisur und Abend-Make-up in den Pool steigen, um sich mit dem Rücken zur Aussicht stundenlang selbst zu fotografieren. Ich nutze solche Momente als Resilienz- und Achtsamkeitstraining und genieße das Gefühl der Freiheit wie eine Nüchterne, die Menschen im Vollsuff beobachtet.
Ob es uns gefällt oder nicht, wir alle müssen menschlich und unternehmerisch akzeptieren, dass die Digitalisierung im Jahr 2024 Menschen hervorgebracht hat, die besondere Bedürfnisse haben. Das können wir nicht mehr ändern. Was wir ändern können und müssen, ist: wie wir darauf reagieren.
Welche Gäste will ich?
Keiner wird alle Gästegruppen glücklich machen, dazu sind die besonderen Bedürfnisse zu divers.
Die Gretchenfrage lautet deshalb: Welche Gäste will ich? Plus: Wessen besondere Bedürfnisse kann, welche will und welche muss ich in Folge als Gastgeber:in befriedigen?
Ob das eine Selfie-Happy-Hour ist, eine Augmented Reality Brille, die beste Aussicht auch bei Nebel garantiert, während der Gast barfuß im Matsch steht, eine Rollator-Rampe für reiselustige Silver Surfer 80-plus oder die handyfreie Zone und das Essen bei Kerzenschein für das Digital-Detox-Hotel…
Alles ergibt Sinn, wenn es die Gäste glücklich macht, die man ansprechen will, und das ungebremst menschlich und gastfreundlich in allen Kanälen vom Check-in-Roboter bis hin zum Schild, das die Happy-Selfie-Hour kommuniziert.
Vor dem Infinity Pool des „Worlds Best Spa 2024“ steht so ein Schild. Dort werden die Fotozeiten kommuniziert: 10 bis 12 Uhr und 17 bis 19 Uhr.
Wer außerhalb dieser Zeiten Fotos macht, merkt sofort, dass derzeit noch echte Menschen hinter den Pool-Überwachungskameras sitzen. Binnen weniger Minuten kommt ein Spa-Mitarbeitender und erinnert freundlich an die Fotozeiten.
Wenn das nicht hilft, starte ich alle Über-KopfMassage-Duschen gleichzeitig, das spritzt jeden Smartphone-Zombie weg – ich bin halt auch nur ein Mensch.

DIE AUTORIN
Anitra Eggler ist laut ORF „die gefragteste weibliche Stimme zu Nebenwirkungen von Digitalisierung“. Die DigitalisierungsExpertin und Digital-Detox-Pionierin zählt zu den inspirierendsten Vortragsredner:innen unserer Zeit. anitra-eggler.com
Mit dailypoint™ die Gästebindung stärken: Modernes CRM für gezielte, personalisierte Kommunikation und Direktbuchungen.
In einer Zeit, in der Datenfragmentierung und ineffiziente Prozesse die Hotellerie herausfordern, bietet dailypoint™ eine umfassende CRM-Lösung für das Gästemanagement. Die Software integriert Daten aus PMS, CRM und POS in einer zentralen Plattform und schafft so ein einheitliches Gastprofil – den „Golden Record“. Dadurch erhalten Hotels wertvolle Einblicke in die Vorlieben ihrer Gäste und können personalisierte Erlebnisse bieten, die die Gästebindung stärken und Direktbuchungen fördern.
Mit dailypoint™ stehen Ihnen leistungsstarke Marketingund CRM-Tools zur Verfügung, die durch KI und Machine Learning datengestützte Entscheidungen ermöglichen. Datenschutzkonformität und die Einhaltung der DSGVO sind dabei garantiert. dailypoint™ ist die Wahl führender Hotels und Preferred Vendor der „Leading Hotels of the World“. Setzen Sie auf zukunftssichere Technologie und verschaffen Sie sich einen Wettbewerbsvorteil – für begeisterte Gäste und erfolgreiche Hotelbetriebe.


KONTAKT
Dr. Michael Toedt CEO & Founder dailypoint™ T: +49 89 1893569-0 | info@dailypoint.net dailypoint.com
TikTok ist da. Und es wird bleiben.
Für die kommerzielle Nutzung bringt die Plattform eine Unzahl an Herausforderungen. Denn sie ist anders als alle anderen: Schneller, echter, originärer.
Ein Deep Dive mit Social MediaStratege Thomas Meyer.

Warum lieben wir TikTok? Und warum ist die Verweildauer auf der Plattform so immens hoch? (Relativ) einfach: Unser gesteigerter Dopaminausstoß während des Konsums basiert auf dem sogenannten Content Graph. Dieser Algorithmus erkennt unsere Vorlieben und spielt uns nur Inhalte aus, die wir interessant, beziehungsweise unterhaltend, finden.
Und genau das ist der entscheidende Punkt: TikTok hat verstanden, was viele von uns Marketer:innen vergessen haben: Social Media ist pure Unterhaltung. Es ist weder eine Verkaufsplattform noch eine „digitale Broschüre“. Kein Mensch wartet auf unsere Produkte oder Dienstleistungen, wenn sie eine Social Media-App öffnen. Sie erwarten sich, unterhalten zu werden. Und ja, das werden wir auf TikTok.
Der laute Ruf
Es war im Social Media Marketing eigentlich schon immer unsere Aufgabe, unsere Produkte möglichst natürlich und authentisch zu kommunizieren, doch TikTok hat diese Grundregel noch mal auf ein ganz neues Niveau gebracht. TikTok lebt von Echtheit,
Authentizität und purem Entertainment. Und bitte nicht falsch verstehen: Das bedeutet nicht, dass wir witzig sein müssen. Es muss sich echt anfühlen. Und ja, das ist verdammt schwer.
Doch nun zum eigentlichen Thema. Die Branche spricht von mindestens 40 % der GenZ, die weltweit TikTok als Suchmaschine verwenden. Das wäre Platz 4 nach Google, YouTube und Bing. Macht das Sinn? Ja! Definitiv.
Der Weg zur Buchung – die Customer Journey
Das Internet brachte uns Konsument:innen einen fundamentale Vorteil: Wir können nun vor dem Kauf ausgiebig recherchieren. Ja, wir sind konsumgetrieben – unbestritten. Aber wir sind nicht doof. Wir wollen uns vor einem Kauf sicher sein. Und je höher das Risiko – meist wird hier die Höhe des Kaufpreises als Kriterium genommen – desto sicherer wollen wir uns mit unserer Entscheidung sein. Wir besuchen Bewertungsplattformen, sehen uns Vergleichsportale an, checken die Social MediaProfile der Alternativanbieter und, und, und…
Und klar, beim Urlaub handelt es sich um ein sogenanntes High Involvement Produkt und das bedeutet, dass ich mir hier besonders viele Gedanken mache, bevor ich tatsächlich buche.
Und nun liegt es an uns Marketer:innen, in dieser Phase zu „gewinnen“. Die möglichen Maßnahmen hierfür sind vielfältig: SEA, Influencer Marketing (als Proof of Concept), Review Management, gutes Community Management, cross-mediale Touchpoints etc., etc.
UND: die Akzeptanz, dass TikTok als Suchmaschine verwendet wird.
Und ja, natürlich wird TikTok als Suchmaschine verwendet. Wir wollen in unserer Recherchephase echte Meinungen von echten Menschen – leicht aufbereitet und per Video-Vollbild konsumierbar. Wir können als Unternehmen hunderte Male konstatieren, dass wir die besten und schönsten sind –wenn es eine Kundin oder ein Kunde über uns sagt, wird es jedoch immer glaubhafter sein.
Und das tun TikTok-User:innen: Sie sprechen über uns. Und zwar anders als auf Instagram oder anderen Plattformen. Natürlicher, echter, authentischer. TikTok forciert diese Entwicklungen auch. Suchbar ist im Grunde alles: Trends, Keywords, Hashtags, Volltext, Sounds – und diverse Filter stehen auch zur Verfügung. Und sie werden weiter daran arbeiten, uns als User:innen noch länger auf der Plattform zu halten und wir Marketer:innen werden uns weiterhin Gedanken machen müssen, wie wir die Plattform für unsere Zwecke nutzen können.
TikTok ist da. Und es wird bleiben.

Thomas Meyer Gründer, Geschäftsführer & Stratege Büro für Interaktion interaktion.io

Mehr Sicherheit: Für Hotel & Gäste
Mildere Winter, weniger Können und Enthusiasmus bei den Jungen: Der Wintersport steht vor zahlreichen Herausforderungen. Roswitha Stadlober, Präsidentin des Österreichischen Skiverbandes, mit Lösungsansätzen.
die lobby: Welchen Beitrag leistet der ÖSV, damit Schnee auch noch von morgen ist?
Roswitha Stadlober: Als ÖSV tragen wir selbstverständlich eine Mitverantwortung, den Wintersport ökologischer und somit nachhaltiger zu machen.
Die Winter werden milder, aber laut aktuellem Stand der Wissenschaft werden wir Wintersport auch in 50 Jahren noch ausüben können. Allerdings wird es größere Unterschiede von Saison zu Saison geben. Schneearme und schneereiche Winter werden sich stärker abwechseln und generell wird die Schneedecke in niedrigen Lagen ohne technische Beschneiung nicht mehr für einen durchgehenden WintersportBetrieb ausreichen.
Wir setzen uns daher konkrete Emissionsziele und alle Athlet:innen und Betreuer:innen sowie Vereine werden mit Schulungen unterstützt. Im Bereich der Events fordern wir ein zentrales „Klimaticket für Großevents“, um die nachhaltige Mobilität zu fördern.
Wir sind überzeugt, dass die Bewegungsförderung möglichst früh beginnen sollte und wir wollen daher allen Kindern und Jugendlichen in Österreich einen Zugang zum Wintersport ermöglichen.
Denn, wenn die Jugend nicht mehr Skifahren lernt, hat das Auswirkungen auf den Skinachwuchs im Sport und für den touristischen Gast der Zukunft. Wir haben daher zahlreiche Initiativen gestartet, um die Bewegung im Winter vermehrt in der Gesellschaft zu verankern.
Unser Kernanliegen ist die Stärkung und der Ausbau der Wintersportwochen. Diese Initiative treiben wir über das „Forum Wintersportwochen“ voran, welches vom ÖSV gemeinsam mit dem Österreichischen Arbeitskreis Schneesport an Schulen und Hochschulen organisiert wird.

Die FIS Alpine Ski WM 2025 in Saalbach soll dabei zu einem Vorzeigeprojekt für künftige Großevents werden. Außerdem passt man den Trainings- und Rennkalender im Spitzensport an.
die lobby: Neben dem Klimawandel macht sich auch eine gesellschaftliche Veränderung bemerkbar. Wie gelingt es, kommende Generationen für den Wintersport zu begeistern?
Roswitha Stadlober: Es gilt den Stellenwert des Skifahrens zu halten. Das Thema der Leistbarkeit und der Bewegungsmangel bedingt durch Wohlstand und verändertes Freizeitverhalten (Stichwort: Social Media), insbesondere bei Kindern und Jugendlichen, sind immer größer werdende Herausforderungen, denen wir als ÖSV uns stellen.
Und wir fördern den Ausbau von Mattenpisten (Vorbild: Wien) in den urbanen Ballungsräumen außerhalb der Gebirge, um Kindern und Jugendlichen kostengünstig und ohne aufwändige Anreise, das Erlernen der Technik zu ermöglichen.
Von der Politik fordern wir ein Freiluft-Bewegungsgesetz nach dem Vorbild Norwegen, wo Unterricht im Freien an der Natur im Lehrplan fix verankert ist („Friluvtsliv“) und so das Naturerlebnis und die Verbindung zur Natur bereits ab frühester Jugend gefördert wird. Zudem fordern wir die Integration von Wintersport in die Bewegungsoffensive in Kindergärten und an den Schulen durch die Aufnahme in den Ganztagesunterricht bzw. als schulbezogene Veranstaltung.
Vielen Dank für das Gespräch!

Fragen Sie sich, ob Ihre monatlichen Ausgaben für Google Ads gerechtfertigt sind? Sind Ihre Kampagnen effizient? Ein Vergleich der Kosten und Leistungen von Buchungsplattformen kann helfen, die Effizienz Ihres aktuellen Anbieters einzuschätzen.
Beispielrechnung zur Optimierung der Werbekosten
Bei Buchungsplattformen werden in der Regel Provisionen von rund 15 % fällig. Das bedeutet, dass bei einer Buchung von 600 Euro etwa 90 Euro an Kosten entstehen. Die Conversion-Rate zeigt, dass etwa jede 3. Anfrage zu einer Buchung führt. Damit die Werbekosten mit der Plattform-Provision vergleichbar sind, sollten die Kosten pro Anfrage (Conversion) etwa 30 Euro betragen.
Worauf sollten Sie bei der Wahl eines Anbieters achten?
Nicht jeder Anbieter von Google Ads-Lösungen bietet dieselben Vorteile. Behalten Sie daher folgende Punkte im Blick:
Landingpage-Zugriff: Wird die Kampagne auf Ihrer eigenen Website gehostet, sodass Sie die Kontrolle haben? Oder wird eine Subdomain verwendet, auf die Sie keinen Zugriff haben?
Google Ads-Konto: Werden die Kampagnen über Ihr eigenes Konto geschaltet, damit Sie Einblicke und Zugriff auf wertvolle Daten behalten? Oder sind Sie vom Anbieter abhängig?
Transparente Berichterstattung: Bekommen Sie wöchentliche, detaillierte Berichte, die Ihnen zeigen, welche Keywords Conversions gebracht haben und welche Maßnahmen erfolgreich waren? Oder erhalten Sie nur oberflächliche Zusammenfassungen?
Strategien für gesteigerte Sichtbarkeit und Umsatz
Das NCM-Prinzip basiert auf der Verknüpfung von SEA-Kampagnen (Suchmaschinenwerbung) und strategischer Suchmaschinenoptimierung (SEO). Diese Kombination sorgt dafür, dass Ihre Website zur richtigen Zeit die richtige Zielgruppe erreicht und
Ihre Sichtbarkeit maximiert wird. Die regelmäßige Analyse von KPIs und detaillierte Berichte bieten dabei wertvolle Einblicke in Besucherzahlen und Conversion-Rates, um Ihre Marketingmaßnahmen kontinuierlich zu optimieren.
Wir konnten dank der optimierten Google Ads-Kampagnen mit geringerem Budget mehr Buchungen und Anfragen erzielen. Besonders erfreulich ist, dass die Kosten pro Anfrage unter 20 Euro liegen und die gesamten Werbekosten, im Vergleich zu anderen Online-Marketing-Agenturen, dank gezielter SEO-Maßnahmen um die Hälfte gesenkt werden konnten.
SOPHIE NEHER
Marketingleiterin Romantik Hotel „Im Weissen Rössl“
NCM – Ihre Expert:innen für digitales Tourismusmarketing
Die Net Communication Management GmbH aus Salzburg verfügt über 28 Jahre Erfahrung und hat mehr als 1.000 Projekte erfolgreich umgesetzt. Als renommierte OnlineMarketing-Agentur bietet NCM umfassende digitale Strategien, präzise Analysen, WebsiteEntwicklung und maßgeschneiderte Beratung, um Ihre Marke nachhaltig zu stärken und Ihre Zielgruppe effektiv anzusprechen.

KONTAKT
Michael Mrazek Inhaber und Gründer der NCM.at michael.mrazek@ncm.at | ncm.at
Künstliche Intelligenz ist eine der größten Chance unserer Zeit, aber auch Hacker nutzen KI und Deepfakes um uns und unsere Unternehmen anzugreifen. Kriminalanalyst & Wirtschaftspsychologe Mark T. Hofmann erklärt die dunkle Seite der KI und wie wir uns schützen können.


Dark Economy: Hacker mit Kundenservice
Wenn die meisten Personen das Wort „Hacker“ hören, stellen Sie sich 15-jährige Teenager in schwarzen Kapuzenpullovern vor. Doch dieses Bild stimmt nicht: Cybercrime ist eine Wirtschaftsform auf der dunklen Seite, die sich von der „normalen Wirtschaft“ in kaum etwas unterscheidet.
Viele Ransomware-Gruppen agieren eher wie mittelständische Unternehmen. Sie haben Kundenservice, Qualitätsmanagement, Personen die Verhandlungen um die Höhe von Lösegeldern führen und Fachkräftemangel.
Laut Statista könnten die globalen Kosten für Cybercrime bereits 2025 auf 10,29 Billionen Dollar steigen. Um dies in den Kontext zu bringen: Wenn Cybercrime ein Land wäre mit Bruttoinlandsprodukt, wäre es die drittgrößte Volkswirtschaft der Welt nach den USA und China. Es ist eine regelrechte „Dark Economy“. Und genauso wie generative KI für große Veränderungen auf der guten Seite sorgt, wird sich auch die Bedrohungslandschaft auf der dunklen Seite verändern.
KI & der Faktor Mensch
Cybercrime ist nicht nur ein technisches, sondern auch ein psychologisches Thema. Es sind Menschen, die auf Links klicken, es sind Menschen, die Anhänge öffnen und es sind Menschen, die in der Deutschen Bahn zu laut über sensible Themen telefonieren oder den Laptop unentsperrt stehen lassen und ins Bordbistro gehen.
Viele glauben noch immer, dass sie Phishing Mails leicht erkennen würden, da diese oft Rechtschreibfehler enthalten und niemals auf den Enkeltrick reinfallen würden, da sie die Stimme ihrer Familienmitglieder sicher erkennen können. Doch durch KI werden die Karten neu gemischt. In Zeiten von Chat GPT können Hacker perfekte Phishing E-Mails auf Knopfdruck generieren und durch Deepfakes ist es möglich, die Stimme ihrer Kinder oder Enkel einfach aus TikTok-Videos zu klonen. Der Enkeltrick ist erwachsen geworden: Plötzlich können Täter mit der echten Stimme des Sohnes oder der Tochter anrufen und das kann sehr überzeugend sein.
Cyber-Angriffe nehmen stark zu, die ÖHV hat ihr Informations- und Schulungsangebot zum Thema Cyber-Security deshalb ausgebaut:
Die Grundelemente sind fast immer gleich: Hacker nutzen Zeitdruck, Emotionen und bitten um ungewöhnliche Ausnahmen. Wann immer diese drei Elemente zusammenkommen, sollten Sie gedanklich einen Schritt zurücktreten und skeptisch werden:
• Ist die E-Mail wirklich vom Zoll?
• Würde Ihre Bank am Telefon nach dem Passwort fragen?
• Ist die E-Mail wirklich vom Vorgesetzen?
KI ist eine Chance, aber es wäre naiv, die Risiken zu ignorieren.
Beim ÖHV-Kongress in Innsbruck veranschaulicht
Mark T. Hofmann, wie Hacker KI & Deepfakes bereits nutzen und wie wir uns, unsere Unternehmen und Familien schützen können.




Hier finden Sie Infos und Tipps u.a. zu folgenden Themen:
• Cyber-Security in meinem Betrieb –wo fange ich an?
• Cyber-Notfallplan für Hotels
• Krisenkommunikation
• Cyberversicherung – ja, nein, vielleicht?
• Phishing
• Sachschäden und Diebstahl
• Videoüberwachung – was rechtlich gilt

Mark T. Hofmann ist Kriminal- & Geheimdienstanalyst und Organisations psychologe (M.A.). Er hat sich auf das Verhaltens- & Cyber-Profiling spezia lisiert, gilt als einer der bekanntesten Profiling-Experten und ist ein gefragter Keynote Speaker bei Kongressen. mark-thorben-hofmann.de



Von 22. bis 24. Jänner 2025 wird Innsbruck zum Zentrum der österreichischen Hotellerie. Der ÖHVKongress 2025 steht unter dem Motto „Neue Wege, neue Gäste.“ und verspricht spannende Impulse für eine zukunftsorientierte Gästeansprache, innovative Marketingstrategien und die Chancen der digitalen Transformation.

Neben hochkarätigen Vorträgen und Workshops erwartet alle Teilnehmenden natürlich auch ein inspirierendes Rahmenprogramm und Abende voller Netzwerkchancen und Entertainment.
Eröffnungsabend in der Dogana
Mittwoch., 22. Jänner
Nach der offiziellen Kongresseröffnung lädt die historische Dogana im Congress Innsbruck zu einem festlichen Abend mit Live-Musik von Thomas Daubek und Band ein. Ein Gala-Menü sowie eine Weinverkostung runden den Abend ab und sorgen für einen genussvollen Auftakt.



Hauptabend im Salzlager Hall
Donnerstag, 23. Jänner
Am zweiten Kongressabend führt der Weg in das beeindruckende Salzlager Hall, eine Location, die mit ihrer besonderen Atmosphäre und den hohen Gewölben beste Voraussetzungen für eine unvergessliche Gala bietet. Sie werden von einzigartigen Performances empfangen: Spiegel-Walking-Acts und eine UV-Seifenblasenshow aus Mailand sorgen für außergewöhnliche Highlights. Ab 22:30 Uhr warten eine LED-Show und Airbrush-Tattoos, bevor DJ George D die Tanzfläche bis 02:00 Uhr zum Leben erweckt. Shuttle-Busse bringen Sie natürlich bequem von Innsbruck ins Salzlager und wieder zurück.
Nutzen Sie die Gelegenheit, Teil dieser einmaligen Branchen-Veranstaltung zu werden!
Mehr Infos zu Programm und Tickets gibt´s auf: oehv.at/kongress
55. ÖHV-Generalversammlung – das Programm für Mitglieder

Alle ÖHV-Mitglieder sind herzlich zur Generalversammlung eingeladen. Am Programm stehen unter anderem der Rückblick des Generalsekretärs, wichtige Statutenanpassungen und natürlich die Wahl des neuen ÖHV-Präsidiums. Diese exklusive Veranstaltung bietet allen Mitgliedern also einmal mehr die Gelegenheit, sich einzubringen und die Weichen für die Zukunft der Branche zu stellen.
Mittwoch, 22. Jänner 2025, 16:00 – 18:00 Uhr
Congress Innsbruck, Rennweg 3, 6020 Innsbruck
Anmeldung: oehv.at/kongressanmeldung
Das 4-Sterne-Superior Hotel Steiner in Obertauern vereint Familienfreundlichkeit und Luxus. Dank innovativer Hotelsoftware werden höchste Ansprüche erfüllt, was sowohl den Gästen als auch dem Team das Leben erleichtert.
Insgesamt 55 Mitarbeiter:innen kümmern sich mit „viel Herzglut“ – unter diesem Motto widmet sich die Belegschaft den höchsten Qualitätsstandards – um das Wohl der Gäste im 170-Betten-Betrieb, damit der Aufenthalt „Echt Steinerisch“ wird. In Größenordnungen wie diesen, ist ein Hotel-PMS zur Organisation unverzichtbar. Vor knapp vier Jahren folgte diesbezüglich der Wechsel im Hotel Steiner zu CASABLANCA hotelsoftware, der bis heute nicht bereut wurde: „Die Zusammenarbeit mit CASABLANCA ist ausgezeichnet, das habe ich zuvor noch bei keinem PMS-Anbieter erlebt. Der Umstieg war einfach und auch die Betreuung und Nachbetreuung waren sehr gut“, so die Hotelchefin. Besonders die intuitive Handhabung und die unkomplizierte Erlernbarkeit des Hotelprogramms wissen zu überzeugen: „Das ist für uns ein großer Vorteil. Wenn wir neue Mitarbeiter:innen bekommen, ist die Einschulung schnell erledigt. Darüber hinaus schätzen wir es sehr, wie innovativ gearbeitet wird. Die Abläufe werden kundenzentriert immer weiter vereinfacht, was der Rezeption die Arbeit natürlich stark vereinfacht“.
Wellness- und Spaverwaltung
Auch bei der Verwaltung und Organisation der Wellness- und Spatreatments vertraut man auf die Tools von CASABLANCA und zeigt sich von der praxisnahen Entwicklung und Einrichtung der Wellness- und Spaverwaltung überzeugt: „Wir haben dem CASABLANCA-Team erläutert und aufgezeigt, wie wir gerne mit der Wellnessverwaltung arbeiten würden und dann wurde das genau an unsere Wünsche angepasst. Die Entwicklung erfolgte Hand-in-Hand. Es ist toll, dass so praxisnahe gearbeitet wird. Wir haben drei Mitarbeiterinnen mit drei verschiedenen Spezialbereichen und Anwendungen, aufgeteilt auf vier Räume. Die Spa- und Wellnessverwaltung erleichtert die Organisation daher immens“, so die passionierte Hotelleiterin.

Auch die Onboarding- und Technik-Abteilung von CASABLANCA profitierte vom offenen Austausch mit dem Team vom Hotel Steiner, da durch den Dialog viele Bedürfnisse der Wellness-Hotellerie herausgearbeitet werden konnten, welche nun wiederum in die Entwicklung aufgenommen wurden.
Nachhaltige Partnerschaft
Neben den zahlreichen Features und Tools des PMS, ist auch die Servicierung und Dienstleistung ein sehr wichtiger Punkt in Sachen Hotelsoftware: „Der Support und die Betreuung durch die Technikabteilung sind einfach super – wir sind sehr zufrieden. Man hat immer den richtigen Ansprechpartner und fühlt sich ständig gehört.“
Das Fazit nach den ersten vier Jahren mit CASABLANCA hotelsoftware? Ich würde CASABLANCA hotelsoftware nicht nur weiterempfehlen, ich habe es bereits mehrfach weiterempfohlen.
ANDREA STEINER

KONTAKT
CASABLANCA hotelsoftware GmbH Johannes Ehrhart casablanca.at
Wer es wirklich wissen will, ist mit unseren Abo-Modelle bestens bedient. Die bieten nämlich doppelten Mehrwert: umfassendes Know-how zu einem unschlagbaren Preis. Checken und buchen!

ABO: 12 Webinare bzw. 4 Module zum Vorteilspreis
Webinar-Reihe: 360° Housekeeping
Housekeeping ist mehr als Sauberkeit – es birgt Potenziale zur Ressourcenoptimierung und Kostensenkung. In dieser praxisorientierten Webinarreihe lernen Sie, Arbeitsprozesse zu verbessern, Mitarbeiter:innen effizient einzusetzen und Kosten intelligent zu managen.
Das Abo bietet 12 1,5-stündige Sessions zu Themen wie Reinigungsmittel-Einsatz, Lagerverwaltung, nachhaltige Strategien und technologische Innovationen. Nach jeder Session gibt es eine 30-minütige Q&A-Runde.
oehv.at/housekeepingabo
Webinar-Reihe: Generation Z erfolgreich fördern und führen
Diese Webinarreihe richtet sich an Fach- und Führungskräfte in der Hotellerie, die junge Talente der Generation Z besser verstehen und gezielt fördern möchten. Praxisnahe Strategien stehen im Fokus –von klaren Strukturen über Mitgestaltungsmöglichkeiten bis hin zu empathischer Führung.
Der Lehrgang umfasst vier Module mit je drei Sessions, die verschiedene Aspekte der Lehrlingsausbildung abdecken. Wer das Komplett-Abo bucht, profitiert zusätzlich von individuellen Coaching-Einheiten zur Vertiefung der Führungskompetenzen.
oehv.at/genzabo
Webinar-Reihe: 360° Arbeitsrecht im Hotel
Mit dieser Webinarreihe, bestehend aus insgesamt 12 Webinaren, bleiben Sie im Arbeitsrecht stets auf dem neuesten Stand!
In den monatlichen Sessions, die jeweils 1,5 Stunden dauern, können Führungskräfte und Mitarbeiter:innen ihr arbeitsrechtliches Know-how praxisnah vertiefen und direkt anwenden.
oehv.at/arbeitsrechtabo
Die Webinare/Module können auch einzeln gebucht werden.
Verkauf an der Rezeption –
Am Telefon & Face-To-Face
Dienstag, 18. Februar 2025, Wien
Verkaufen bedeutet mehr als Standardphrasen abzuspulen. Es geht darum, Interesse am Gast zu zeigen, dessen individuelle Bedürfnisse zu erkennen und darauf aufbauend ein unwiderstehliches Angebot zu platzieren. Im Tagesseminar lernen die Teilnehmer:innen auch, auf Einwände zu reagieren, um den Abschluss erfolgreich zu gestalten.
Der richtige Umgang mit Beschwerden im Hotel
Mittwoch, 19. Februar 2025, Wien
Beschwert sich ein Gast, sind Mitarbeiter:innen ganz besonders gefordert. Dabei kann gerade ein souveräner Umgang mit Beschwerden aus kritischen Gästen Stammgäste machen. Genau dafür erhalten die Teilnehmer:innen in diesem Seminar Tipps und Tricks rund um sachliche Gesprächsführung.
Infos & Anmeldung:
So geht Digitalisierung und Automatisierung im Hotel
Mittwoch, 26. Februar 2025, Salzburg
Um wettbewerbsfähig zu bleiben und den sich verändernden Gästebedürfnissen gerecht zu werden, ist eine Digitalisierungsstrategie für Hotels von großer Bedeutung. Wie Sie die digitale Agenda für Ihr Hotel planen, lernen Sie im Tagesseminar.
Erfolgsfaktoren im Tagungsmarkt:
Innovative Ansätze zur Umsatzsteigerung in Hotels
Mittwoch, 27. Februar 2025, Salzburg
Der Tagungsmarkt befindet sich mitten im Veränderungsprozess. Speziell die schnell voranschreitende Digitalisierung ändert nicht nur Veranstaltungsformate, sondern auch die Anforderungen an Hotels. Verstehen Hotels diese Anforderungen und Prozesse, können sie sich rechtzeitig darauf einstellen und aktiv mitgestalten.


ÖHV-FORUM Wien
Im Oktober traf sich die Branche beim ÖHVFORUM „KI im Hotel“ im Anantara Palais Hansen Vienna. Nach inspirierenden Vorträgen und einer spannenden Diskussionsrunde mit Praktiker:innen klang der Nachmittag bei DJ-Live-Performance und Weinverkostung stimmungsvoll aus.
ÖHV-Unternehmerakademie
22 neue Absolvent:innen der ÖHV-Unternehmerakademie feierten ihre Diplomüberreichung im exklusiven Ambiente des Park Hyatt Vienna.


ÖHV-Abteilungsleiterakademie
Wir gratulieren den 25 Absolvent:innen der ÖHV-Abteilungsleiterakademie 2024!

Wer möchte die besondere Italianità nicht auch in seinen Gastronomiebetrieb schmecken?
Ab sofort ist das exklusiv für Lavazza Gastro-Partner möglich: die neuen drei Blends der Tales of Italy-Range des italienischen Kaffeerösters erzählen Kaffeegeschichten, getragen von einer intensiven, italienischen Seele.
Sie gehören zu den ikonischsten Städten Italiens: Mailand, Venedig und Rom – und jede von ihnen prägt eine einzigartige Kultur und Architektur. Diese Besonderheiten zeigen sich auch in der jeweiligen Caffè-Kultur, die Lavazza mit den drei Blends der neuen Premium-Range Tales of Italy einfängt. Sie spricht qualitätsbewusste Caffè-Expertinnen und Experten an, die das Besondere schätzen. Die Mischungen kommen im modernen Pop-Art Design daher und enthalten ausgewählte Kaffee-Blends mit fermentiertem Robusta und brasilianischem Arabica Cereja Apassita. Diese hochwertigen Kaffeesorten zeichnen sich durch exotische Aromen, süße weinige Anklänge und Honignoten aus.

Eine Aromareise durch Italien: „The New Wave of Italian Blending“
Italianità, per favore: Die drei sorgfältig kuratierten Blends der Tales of Italy Kollektion sind inspiriert von dem Flair der “Caffetteria Italiana” und spiegeln das authentisch italienische Caffè-Ritual wider. Und dafür hat der italienische Kaffeeröster für jede Mischung hochwertigste Bohnensorten ausgewählt: gewaschener Arabica aus Mittel- und Südamerika, natürlicher Arabica aus Brasilien und gewaschener Robusta „Cru of Origin“ aus Indien und Indonesien.

Das Besondere: Zwei der neuen Blends enthalten fermentierten Robusta – dadurch veredeln diese Bohnen den Caffè-Geschmack mit weinartigen Aromen und besonderer Vollmundigkeit. Der dritte Blend enthält brasilianischen Arabica Cereja Apassita. Bei dieser besonderen Sorte reifen die Kaffeekirschen länger am Strauch (30 Tage) und entwickeln dadurch einen höheren Zuckergehalt, der dem Caffè eine besondere Süße mit leichten Honig-Aromen verleiht und den typisch italienischen Körper perfekt ergänzt. Eine schonende Langzeitröstung sorgt dafür, dass sich die Aromen perfekt entfalten und die Weichheit und das Bouquet der Fermentation bewahrt werden.
KONTAKT: Lavazza Kaffee GmbH Wien | AT.kundenservice.AFH@lavazza.com | lavazza.at




LÜ-Hotel in der Mitte –Katharina Gappmayr & Elisabeth Lauche


Wir freuen uns über 17 neue Mitglieder im vierten Quartal: Alpines Gourmet Hotel Montanara, Flachau • Stift Schlägl Seminarzentrum, Aigen-Schlägl • Motel One Innsbruck, Innsbruck • Hotel Gasthof Brandstätter, Salzburg • Hotel Lavendel, Windischgarsten • Riverresort Donauschlinge, Haibach ob der Donau • Gasthof Kleefeld, Strobl am Wolfgangsee • Hotel Hoffinger, Wien • Hotel Florum, Wien • Mount Med Resort, Wildschönau-Oberau • Berghotel Jaga-Alm, Zell am See • B&B Hotel Wien-St.Pölten, St. Pölten • Parkhotel Brunauer, Salzburg • All-Suite Resort Paznaun, Galtür • Gut Sonnberghof Naturhotel, Mittersill • Hotel Brückenwirt, St. Johann i.Pg. • Hotel Café Karol, Wien
Wer jetzt nicht automatisiert, verliert! Schnelle Kommunikation entscheidet heute über Buchungen.

Unsere Kommunikationsplattform arbeitet rund um die Uhr automatisch für Sie, während Sie sich persönlich um Ihre Gäste kümmern.




24/7 über Chatbots, Telefonbots, Mail und Messenger – sichern Sie jede Anfrage und entlasten Sie Ihr Team!

onlim.com/oehv/

Ihre Gäste tanken Energie –Sie entscheiden wie

Green Mobility Pay von Global Payments
Installation von E-Ladestationen bei Ihrem Hotel
Für bestehende und geplante Infrastruktur
Preistransparenz für Kund:innen
Automarken-unabhängige Lösung
Sichtbarkeit der Ladestation in Navigationsdiensten
QR-Code scannen und Angebot einholen

